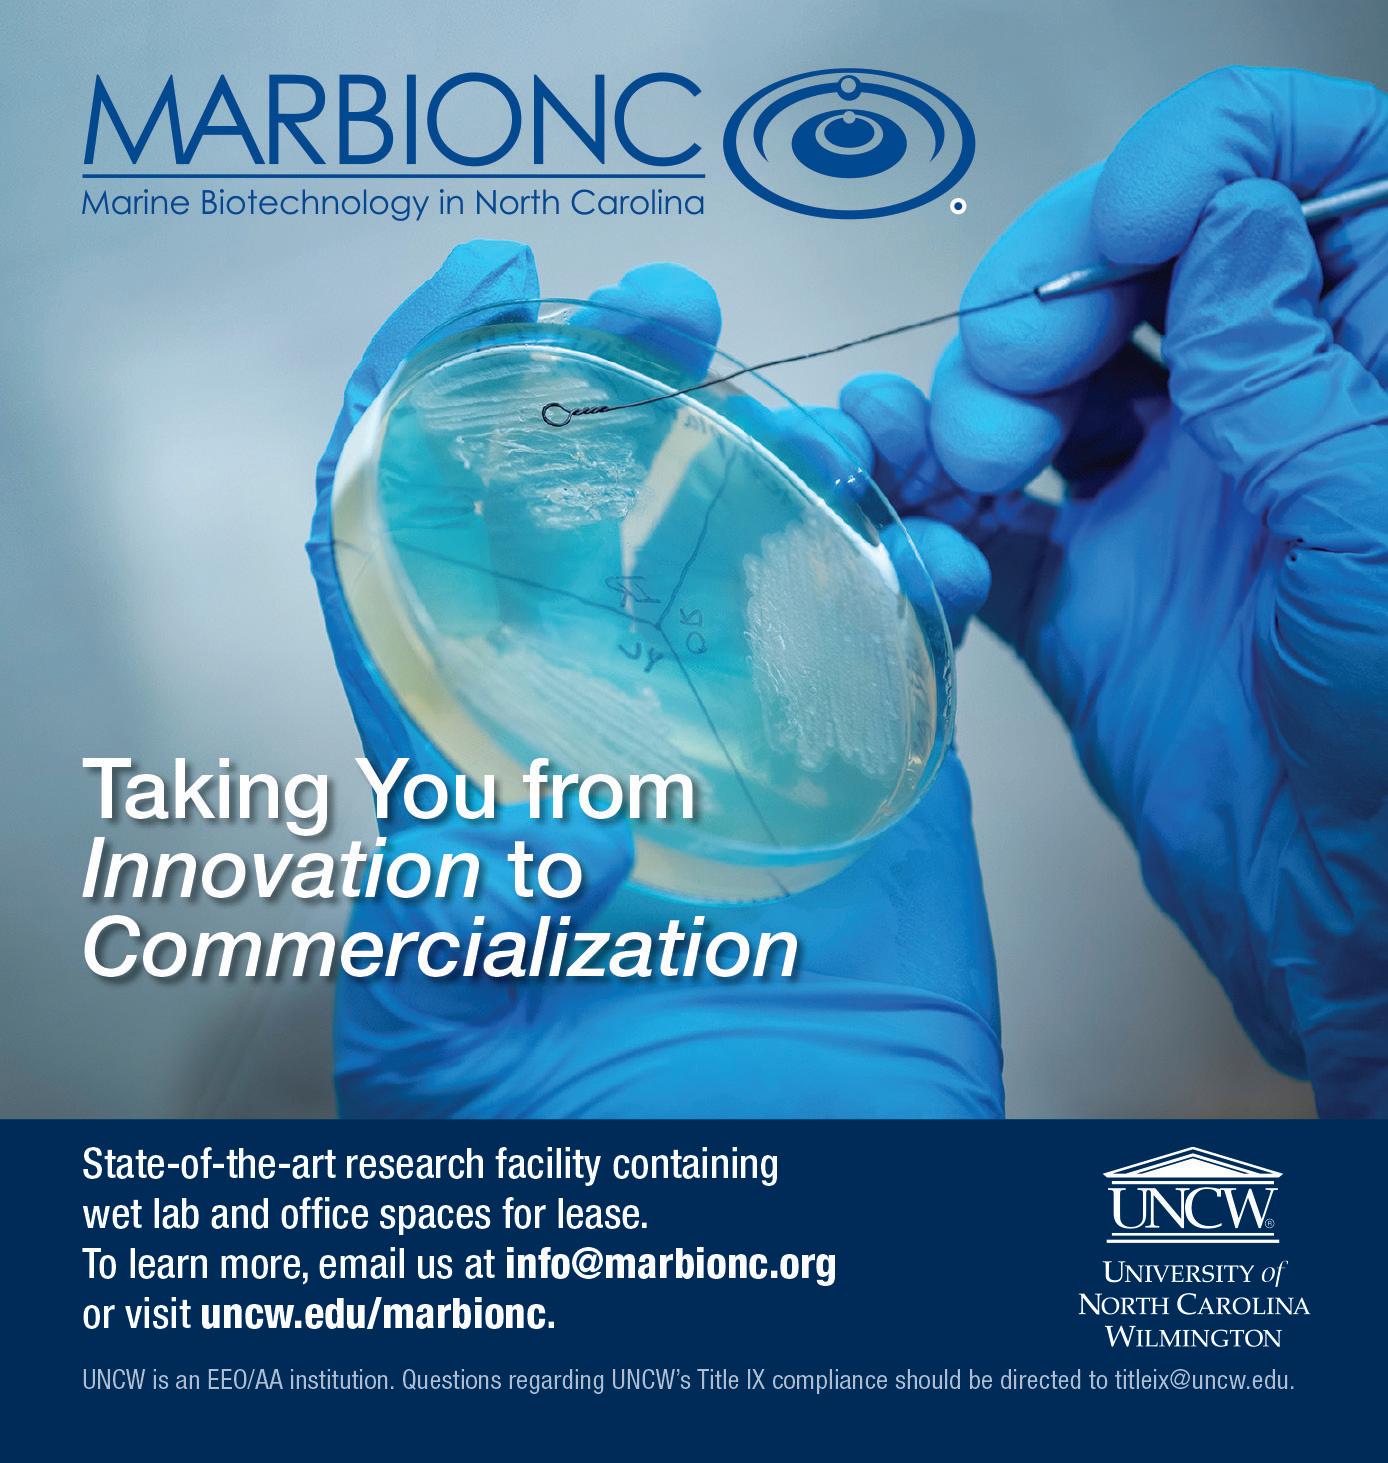

theSetting stage
North Carolina’s unique approach to economic development ensures everything that businesses need to succeed, from renewable energy to workforce, is available.







Tax credits are transforming North Carolina’s vacant mills. Startups, established companies and residents are embracing the renovations, which combine work, live and play opportunities.
CHARLOTTE
Companies choose the Charlotte region because of its skilled workers, who benefit from educational opportunities and enjoy an unmatched quality of life.
EAST
The renewable energy industry is electrifying eastern North Carolina, where land is cheap, skilled labor plentiful and supply chain opportunities abound.
TRIAD
Logistics, location and labor have been at the heart of the Triad’s economic successes. Investments are ensuring the success extends through the Carolina Core.



TRIANGLE
Technology companies — from startups to global players — and their workers find everything they need or want in North Carolina’s Triangle region.
WEST
Western North Carolina leaders are balancing the region’s growing popularity with the needs of its businesses and residents, creating a better future for all.











64 acres, Smart Sites qualified Future US 74 Bypass (0.4 mi); US 74 (1.25 mi)
Sale price: $20,000 per acre
40 15 acres, Smart Sites qualified US 401 and US 1 (8-10 mi)
Sale price: Negotiable
130.46 acres, Smart Sites qualified US 264 Bypass / adjacent Hwy 264 / Distance: 2 mi
Sale price: $35,000 per acre

Smar t Sites are a slam-dunk choice for companies that are ready to grow now. Faster constr uction , fewer uncertainties and less risk for companies and site selectors alike — that ’s the genius of the Smar t Sites qualification program. But that ’s not all. Our many Smar t Sites are located in some of the best places in Amer ica to live and do business







10 REASONS TO BE IN N.C.
1. A BUSINESS FRIENDLY TAX ENVIRONMENT
North Carolina’s 2.5% corporate income tax rate is the lowest among the 44 states with the levy. Overall, North Carolina has the third-lowest business tax burden in the U.S., according to a comprehensive 2018 Anderson Economic Group study that considers 11 taxes levied on businesses.
2. NATIONALLY RECOGNIZED BUSINESS CLIMATE
North Carolina consistently finishes among the top two states in well-regarded national business rankings. In 2021, North Carolina’s business climate was named No. 1 in the country by Site Selection magazine, a title it shared with Georgia the year prior. In 2019, North Carolina remained Forbes’ choice as the nation’s best state for business — for the third year in a row. Meanwhile, CNBC placed North Carolina No. 2 in its 2021 ranking of America’s Top States for Business.
3. FAST-GROWING POPULATION AND TALENT POOL
North Carolina’s population is expected to grow to 11.1 million in 2025 and reach 11.7 million by 2030. The state’s population grew 9.5% between the 2010 and 2020 U.S. Censuses, earning it a 14th U.S. House seat. That growth also helps fill the workforce pool, which is stocked with local talent. Residents have access to top-tier training. Students are earning degrees at 53 college and universities statewide. North Carolina’s 58-campus community college system is the nation’s third largest and a national model for customized workforce training.
4. AFFORDABLE BUSINESS OPERATING COSTS
North Carolina’s cost-effective business environment is clear across several measures, including construction costs (16% below the national average in metropolitan areas) and industrial electricity costs (about 10% below the U.S. average). In fact, North Carolina’s labor, energy and tax costs are all well below the national average, according to Forbes, and rank as the nation’s fourth lowest overall.
5. LOCATION AND LOGISTICS TO REACH MILLIONS
North Carolina’s central East Coast location and superb road transportation network provide access to more than 178 million customers within a day’s drive. The state’s two deep water seaports and two Class 1 rail carriers enable companies to reach millions more domestic and international customers. North Carolina boasts several regional airports and four international airports including
the nation’s sixth-busiest in 2020 based on enplanements in Charlotte and the very well-connected Raleigh-Durham International Airport.
6. LEADERSHIP IN RESEARCH AND INNOVATION
North Carolina public and private universities excel in research and development. Duke University, University of North Carolina and N.C. State University ranked among the top 100 universities worldwide granted U.S. utility patents in 2019. The state also is home to several research parks, including the nation’s largest — Research Triangle Park — which is home to more than 250 of the world’s most innovative companies employing more than 50,000 people.
7. QUALITY OF LIFE
North Carolina’s low cost of living and family friendly reputation make it an ideal place to call home. Residents enjoy a moderate climate year-round and unique access to a variety of stunning natural landscapes, flanked by the Great Smoky Mountains and Blue Ridge Mountains to the west and 300 miles of coast to the east.
8. STRONG MANUFACTURING AND GROWING TECHNICAL WORKFORCE
At more than 459,000 employees in 2021, North Carolina has the largest manufacturing workforce in the Southeast and the ninth-largest in the country. Over the past five years, the state’s technology industry jobs increased 18%, seventh highest in the nation and well above the national average of 8.9%.
9. PERFORMANCE-BASED, TARGETED INCENTIVES
North Carolina offers eligible companies state and local programs that lower their costs and increase their global competitiveness, including performance-based grants tied to job creation. In recent years, legislators have significantly expanded possible grants for projects that create large-scale employment and investment.
10.
ECONOMIC DEVELOPMENT ASSISTANCE
The Economic Development Partnership of North Carolina helps companies of all sizes identify sites, navigate economic development incentives, find workforce solutions and more. If you are interested in locating or growing your business in North Carolina, call 919-447-7744, email clientservices@edpnc.com or visit edpnc.com.
source:

PROJECT E DITOR
Pete Anderson
PROJECT ART DIRECTOR Peggy Knaack
CONTRIBUTORS
Kathy Blake, Lawrence Bivins, Teri Saylor, Katherine Snow Smith
PUBLISHED ANNUALLY BY
PUBLISHER
Ben Kinney
EDITOR
David Mildenberg
ASSOCIATE EDITORS
Colin Campbell, Jennings Cool, Cathy Martin
SENIOR CONTRIBUTING EDITOR
Edward Martin
SPECIAL PROJECTS EDITOR
Pete Anderson
CREATIVE MANAGER Peggy Knaack
ART DIRECTOR
Ralph Voltz
ACCOUNT DIRECTORS
Sue Graf, Melanie Weaver Lynch
MARKETING COORDINATOR
Jennifer Ware
AUDIENCE DEVELOPMENT
SPECIALIST
Scott Leonard
1230 W. Morehead Street, Suite 308
Charlotte, NC 28208
Telephone: 704-523-6987
All contents copyright ©2021
Old North State Magazines LLC
PRESIDENT David Woronoff
THE FUTURE IS HERE
The COVID pandemic has altered much of life as we knew it. The popularity of online shopping is skyrocketing, for example, and working remotely is here to stay. But at least one constant remains: North Carolina is a great place to do business.
Gene McLaurin, the business and political veteran who Gov. Cooper recently named board chairman of Economic Development Partnership of North Carolina, the public-private booster of tourism and business statewide, said business relocations and expansions in 2020 — the height of the pandemic — are expected to generate $6.3 billion in investments, the most in the past decade. And they’ll add more than 20,000 jobs, only a few less than 2019’s 21,675, the best in the past 10 years.
Those numbers certainly support Site Selection magazine’s 2021 proclamation that North Carolina’s business climate was best. And while it’s important to note that the state earned that honor in 2020, too, though shared with Georgia, it’s not resting on its laurels. North Carolina is working today to ensure businesses succeed tomorrow.
Reminders of North Carolina’s strong manufacturing past stand statewide. Vacant since economic forces halted a large portion of furniture, tobacco and textile production, these mills are being renovated and repurposed thanks to tax credits. They are launching startups, providing homes to established companies and offering the work-playlive situations that many of today’s workers seek.
Many of those mills were built because of access to inexpensive and
reliable power. In eastern North Carolina solar and wind energy efforts are attracting residents and businesses. Some are seizing opportunities as links in the renewable-energy supply chain, while others, such as tech giant Google, are using the clean power to meet environmental goals.
Tech companies, including Apple, which recently announced a $1 billion investment statewide are selecting North Carolina because of research and workforce opportunities. The latter was a main reason that electric vehicle maker Arrival choose the Charlotte region for two factories and its North American headquarters.
A top-notch quality of life plays into many businesses and workers choosing North Carolina. While its 300 miles of coast certainly draws some, many others are setting up shop or working remotely in its mountains. So, local leaders are clearing the way — expanding industrial parks, improving health care options and ensuring workers are skilled and housed. It’s a similar situation in the Triad, where Piedmont Triad Airport mixes regular flights with business development and two megasites await tenants.
Each business’s needs are unique, and all can be met in at least one of North Carolina’s 100 counties. A statewide economic development team, which was recently named the country’s best by Development Counsellors International, and local teams are ready to help find your future in North Carolina.
— Pete Anderson, project editor

MOST VALUABLE PLAYER
Gene McLaurin brings years of political, business and economic development experience to his new position — chairman of the Economic Development Partnership of North Carolina’s 17-member board. He shared his thoughts on the team effort that keeps the state’s award-winning business climate at the top.

Economic development is a team sport in North Carolina. From the mayor of the smallest town to the governor, local and statewide economic development organizations, and businesses themselves, everyone has a role. Gene McLaurin has played every position.
N.C. Gov. Roy Cooper named McLaurin board chairman of Economic Development Partnership of North Carolina, the public-private partnership that leads business expansion and recruitment, along with tourism promotion, last year. He has served on the board since 2017.
McLaurin is familiar with public office. He’s an eight-time mayor of Rockingham and served one term in the N.C. Senate. His district included Richmond County, where he grew up and attended Richmond Community College — part of the 58-campus system that customizes workforce training — before earning a degree at UNC Charlotte.
McLaurin has spent more than 40 years in the petroleum industry, first as Southeast division general manager at TOTAL Lubricants USA and now president of Quality Oil and Gas Co. He also is vice president of North Carolina Petroleum Marketers Association’s board.
During those four decades, North Carolina racked up economic honors. But that doesn’t mean it’s time to rest. McLaurin shared what he brings to his new role and his thoughts on North Carolina’s economy: its current state, where it’s headed and what it offers expanding and relocating businesses.


Headquartered in Raleigh, the Economic Development Partnership of North Carolina oversees economic development projects and tourism promotion statewide.
WHAT UNIQUE EXPERIENCES AND ABILITIES DO YOU BRING TO YOUR NEW ROLE?
While I was a state senator in 2014, then-state Secretary of Commerce Sharon Decker asked me to support the creation of a public-private partnership to help the state be nimble and creative in its approach to economic development. Although I wasn’t in the majority party, I supported it because of my private-sector business experience and almost two decades in public service. Gov. Cooper appointed me to the EDPNC board in 2017. We have known each other for more than 20 years. We first met when he was a young legislator from Nash County and I was Rockingham’s young mayor. When EDPNC Board Chairman Frank Emory Jr. stepped down because of his increased responsibilities at Winston-Salem-based Novant Health, Gov. Cooper asked me to serve as chairman. I was excited to accept the role. I’ve seen how effective EDPNC has become and how its CEO, Chris Chung, staff and board — nine members appointed by Gov. Cooper and four each from state Senate Leader Berger and House Speaker Moore — have collaborated to improve North Carolina’s competitiveness and assisted companies statewide. I bring more than 40 years of business experience managing large international companies and smaller North Carolina-based ones. I understand the importance of the public and private sectors working together. I worked in a bipartisan way, and my voting record reflects that. Our board works in a bipartisan manner. We all want economic prosperity for our residents and communities.
WHAT WOULD YOU LIKE TO SEE ACCOMPLISHED DURING YOUR TENURE AS CHAIRMAN?
EDPNC quickly earned the respect of local economic developers, elected officials and site consultants. During 2020, the year before I became chairman, EDPNC and its local and state partners finished strong, recruiting corporate relocation and expansion projects despite the pandemic. Those wins are expected to create more than 20,000 jobs and $6.3 billion in investment. The investment total was the state’s largest in the past decade, and the jobs count was only slightly less than the decade-topping 21,675 announced in 2019. In late 2020, site consultants surveyed by Development Counsellors International ranked EDPNC as the country’s best state level economic development organization. That is a significant accomplishment for a young organization. We’re seeking to invest more in marketing the state as the best place for businesses — and workforce talent — to locate. Our peer states historically have outspent us. While North Carolina usually spends about $1 million annually on business marketing, Georgia, for example, spends $8 million to $12 million and Tennessee and Virginia $8
million to $10 million each. We expect the next state budget to fund more marketing. The legislature also has prioritized reducing regulatory burdens, simplifying the tax structure and ensuring we’re competitive with incentives. We have a tremendously attractive location for companies — domestic and foreign — but many haven’t heard that message. Our “All in North Carolina” advertising campaign has launched, and we’re ready to let more of the world know that North Carolina is a great place to do business.
HOW WOULD YOU SCORE THE STATE’S CURRENT ECONOMY?
It’s very diverse with strong sectors, including food processing, banking, pharmaceuticals, information technology, automotive and aerospace. North Carolina has been one of the top three states for net migration over the past decade. We’ve seen significant growth in knowledge-based professions. The state’s engineering workforce, for example, has grown 18% to more than 45,000 employees over the past five years, which leads the nation. Investing in the workforce of tomorrow is our biggest challenge to maintaining and strengthening our economy. But it’s an opportunity, too. North Carolina’s myFutureNC initiative, for example, has set the ambitious goal of 2 million residents with a high-quality postsecondary degree or credential by 2030. State Commerce Secretary Machelle Sanders recently released First in Talent, the state’s four-year plan for economic development. Workforce investments are the key to building the most prosperous economy for our residents and our businesses. Recently, Secretary Sanders, Chris Chung and I spent a weekend with site consultants from across the country. We learned, among other things, that developing talent and promoting diversity, equity and inclusion policies are key to keeping North Carolina competitive for future jobs and investment. On the international front, EDPNC expects new recruitment opportunities as international companies seek to onshore operations, getting their products closer to the vast pool of North American buyers. Our East Coast location and strong rail, highway, ports and airports position us well to compete for those foreign-direct investments.
HOW CAN NORTH CAROLINA CLOSE THE ECONOMIC DEVELOPMENT GAP SEPARATING ITS RURAL AND URBAN COMMUNITIES?
There isn’t a one-size-fits-all approach to rural community economic development. Each community’s strategy should focus on its strengths rather than duplicating efforts of urban communities. It’s a good idea to think regionally whenever possible, taking advantage of proximity to urban centers. There is great opportunity for rural communities to market their

quality of life, beautiful outdoor spaces, low cost of living and lack of congestion to frustrated urban workers who are seeking small-town life. The COVID pandemic has created more remote workers. They can live anywhere they choose. But to attract them, a community needs reliable broadband internet. North Carolina and other states must bridge the digital divide between urban and rural regions. Providing equitable access to affordable and reliable broadband has been a top priority of Gov. Cooper’s administration.
HOW DOES EDPNC ASSIST COMPANIES THAT ARE ALREADY IN NORTH CAROLINA?
Sometimes megaprojects, such as Apple’s $1 billion statewide investment that includes a 1 million square foot research and engineering hub in Research Triangle Park, overshadow EDPNC’s support for existing businesses. Business retention and growth are as important as recruitment. EDPNC’s existing industry expansions team provides critical services at no cost. Each of its eight regional managers interact with more than 150 businesses annually. They help manufacturers of all sizes, for example, identify hurdles then assemble local, state and federal resources to clear them. They might be workforce-development programs, state incentives, grants to upgrade equipment or renovate buildings, or expertise to implement more efficient practices. EDPNC’s international trade managers help businesses access global markets, meet vetted international distributors and find export financing. They also administer federal State Trade Expansion Program grants, which enable small exporters to attend export education workshops, exhibit at trade shows, translate marketing materials into other languages and localize their business websites in other countries. The trade team assisted more than 630 North Carolina companies in 2020, and those businesses credited EDPNC support with helping them make about $1.1 billion in export sales. EDPNC’s team of small-business advisers provide one-on-one counseling to entrepreneurs about licensing and permitting requirements of starting a business in North Carolina. The team handled nearly 25,000 cases statewide in 2020.
HOW DOES EPDNC RECRUIT AND SUPPORT SMALL BUSINESSES?
Small businesses are an important pillar of North Carolina’s economy. Secretary of State Elaine Marshall recently told me that more than 930,000 small businesses operate in the state, and they employ almost half of its workers. EDPNC recruits and supports businesses of all sizes. It helps them identify sites for location and expansion, navigate state offered incentives, and connect to public and private partners who can address infra-
structure, workforce development and other needs. Each North Carolina community college has a Small Business Center to support entrepreneurs. The UNC System hosts a companion Small Business and Technology and Development Center network, which has 11 locations. The state Department of Administration has an Office for Historically Underutilized Business, which encourages growth of women- and minorityowned businesses. Often the problem isn’t assistance availability, rather it’s sorting through the options to find the best fit.
EDPNC helps with that.
WHERE ARE NORTH CAROLINA’S FUTURE ECONOMIC OPPORTUNITIES?
During the pandemic, we saw strong recruitment of food and beverage processing and manufacturing, information technology, biotechnology and pharmaceutical, and warehouse and distribution businesses. We expect that to continue. We’re committed to seizing fast-developing opportunities in advanced automotive manufacturing, particularly as the world shifts to electric vehicles. North Carolina is home to several shovel-ready megasites that can accommodate large-scale automotive manufacturing. It also hosts operations of 24 of the top 100 global OEM automotive parts suppliers in North America. We have the supply chain to support automotive companies. EDPNC recently dedicated a business recruiter to growing the state’s automotive industry. And as offshore wind projects emerge along the East Coast, we’re positioned to become a key player in the wind-energy industry. The state already has a strong support system — more than 120 active suppliers — for the industry.
WHAT’S THE NO. 1 REASON A BUSINESS SHOULD EXPAND OR RELOCATE IN NORTH CAROLINA?
Our workforce. North Carolina has the Southeast’s largest manufacturing workforce — more than 475,000 employees. Our workforce is diverse. North Carolina is No. 2 in the nation for percentage of women in the technology workforce — 35.4%. Our 10 historically black colleges and universities — the second most of any state — add to that diversity. At nearly 39,000 students, North Carolina enrolls more students in HBCUs than any other state. Our community-college system system has the third-most colleges in the nation and is a model for customized workforce training. Our higher education system, which includes Tier 1 research universities Duke, University of North Carolina and N.C. State, is unparalleled. Their graduates are highly trained. Our private colleges and universities are promoting and expanding their involvement in economic development.

Q&A with Michael S. Fox
President Piedmont Triad Partnership
Q: WHAT IS THE CAROLINA CORE?
A: The Carolina Core is North Carolina’s next economic engine. Bridging the urban crescent between Charlotte and the Research Triangle in central North Carolina, the Carolina Core is defined by diverse assets connected along future Interstate 685 – from megasites to Class A office space, from bustling metros to rural communities. In the Core, businesses and people can access North Carolina’s fastest growing metros, while still benefitting from the perks and quality of life of mid-sized cities and small towns.
From our companies to our people to our deep investments in our communities, the Carolina Core is a future-ready region brimming with opportunity set to transform North Carolina.
Q: WHY SHOULD COMPANIES MAKE THE CAROLINA CORE THEIR NEXT BIG MOVE?
A: This 120+ mile stretch of central North Carolina from west of Winston-Salem to Fayetteville is defined by assets that make the region a globally competitive market – a

smart and growing talent pool of more than 2 million people, access to 30+ colleges and universities, multiple airports, four megasites totaling 7,200 acres of certified land, industrial and urban research parks and more. Companies also benefit from North Carolina’s corporate tax climate, which includes the lowest corporate tax rate in the United States, and competitive incentive programs.
Purpose and vision are at the Core here, with public and private leadership highly engaged on a vision for the future. A spark has caught and strong, innovative companies are investing and growing in the Carolina Core.
Q: WHAT IS IT LIKE TO LIVE IN THE CAROLINA CORE?
A: There’s something for everyone living in the Carolina Core. Affordable housing and excellent public schools leave more money for the things you like – whether that’s practicing yoga in an urban park, hiking and tubing, or attending the PGA Wyndham Championship. And without traffic congestion, you will have more time to enjoy these activities with your family.
Q: WHERE CAN I LEARN MORE ABOUT THE CAROLINA CORE? A: To learn more, visit NCCarolinaCore.com.

PAST AS PROLOGUE
Many of North Carolina’s historic mills, which once produced tobacco, textile, furniture and other goods, are being reborn thanks to tax credits. Residents, startups and established companies are embracing the renovations, where work, residential and recreational opportunities are woven together.
By Lawrence Bivins
It has been nearly five years since Kristi Ellis and her husband, Travis, relocated to Rocky Mount and opened Goat Island Bottle Shop. Craft beers, including gluten-free and non-alcoholic options, specialty wines and packaged foods fill its shelves. It hosts public events year-round, including an Oktoberfest every fall.
The couple’s success led them to acquire Tipsy Tomato, a wood-fired pizza parlor only a few steps from their bottle shop at Rocky Mount Mills, about two years ago. “We get a good base of locals at both businesses,” says Florida-native Kristi. Their customers include people who live, work or both at the mixed-use development, which isn’t far from the intersection of Interstate 95 and U.S. 64. “We do see a lot of people from out of town, too,” she says.
Rocky Mount Mills has seen plenty during its more than 200-year history. Historians believe it’s North Carolina’s second-oldest and longest-active cotton mill, working until 1996. Its time processing cotton was punctuated by two devastating fires, one set by Union soldiers during the Civil War. While it was rebuilt after each blaze, the work was nowhere near the scope undertaken by its current owners.
Raleigh-based Capitol Broadcasting Co. purchased Rocky Mount Mills in 2007 and turned it into 82 acres of residential, educational, commercial and cultural space with the help of tax credits. It wasn’t the first time the owner of television station WRAL had done this. It engineered a similar transformation at American Tobacco Campus in Durham — where it also owns the Durham Bulls, a Triple A baseball team — almost two decades ago.
In addition to 67 loft apartments and 55 single-family “village” homes, Rocky Mount Mills offers views of the Falls of the Tar River and 120,000 square feet of office space. Corporate tenants include a law firm, optical shop, Teach for America’s regional headquarters and offices of the Rocky Mount Telegram, the local daily newspaper. Tipsy




A 1920s aerial view of the R.J. Reynolds Tobacco Co. buildings in downtown Winston-Salem is matched with today’s view of of Innovation Quarter, a cutting-edge collection of renovated spaces for education, research and development, health care and urban living.
Photo credits: Vintage view courtesy of Innovation Quarter. Top photo by Ian McIlwraith for Unsplash.


happening statewide. In Hickory, for example, Hollar Mill, which once produced cotton knit goods, is now home to retail, restaurant and event space. And at the other end of Highland Avenue stands the former Lyerly Full Fashioned Mill, which also dates to the 1930s. The local historic landmark was purchased by global logistics provider Transportation Insight and became its headquarters in 2015 after award-winning renovations.
Turning mills into mixed-use developments that can launch small businesses, meet the needs of existing companies and offer the living amenities that today’s workers seek isn’t a small endeavor. But the payoff is large for all involved.
ECONOMIC INCENTIVES
Credit North Carolina’s vivid but gritty industrial history for sprawling properties such as Rocky Mount Mills. Beginning in the early 1800s, it and others hummed with machines and workers, turning raw materials into a host of products, though none more than textiles, tobacco and furniture. It was one of the South’s most industrialized economies by the 1960s, when manufacturing employed one-third of North Carolina’s workforce. But low-skill jobs dominated, and the per capita income, for example, was just 71% of the U.S. as a whole, according to a 2010 report from N.C. State University’s Institute for Emerging Issues.

North Carolina manufacturing weakened as attitudes about tobacco changed and global trade tariffs were eliminated. Many companies fled offshore, seeking better opportunities, including less expensive labor. In their place grew new industries such as biotechnology, financial services and transportation equipment. But they required custom factories and office space. As the 20th century came to a close, the state was left with empty factories and mills, reminders of former economic glory and targets of vandalism. The situation alarmed preservationists, who were eager to save theses historic structures from demolition.
Legislators responded with an expansion of the state’s tax credits for historic rehabilitation projects in 2006. Its Historic Mill Rehabilitation Tax Credits, which cover industrial buildings — broadly defined to include warehouses and associated offices — grabbed developers’ attention. The program, which was revamped in 2016, according to Preservation North Carolina, starts with a 20% federal tax credit for incomeproducing historic properties. Add to that a 15% state tax credit for renovations that cost up to $10 million. Economic Development Partnership of North Carolina says expenses between $10 million and $20 million receive a 10% tax credit. A 5% bonus is added on all expenses, up to $20 million, for renovations done in Tier 1 or Tier 2 counties. N.C. Department of Commerce annually ranks the economic health of the state’s 100 counties, from the 40 most distressed — Tier 1 — to the 20 least challenged — Tier 3.
The tax-credit program was a brilliant move by North Carolina lawmakers, says Donovan Rypkema, principal at Washington, D.C.-based PlaceEconomics, which provides
Rocky Mount Mills mixes past and present.
CARL LEWIS

research, consulting and training services in support of historic preservation ventures. The program turned what appeared to be a liability — a vast inventory of abandoned properties — into an asset. “It has made a miraculous difference,” he says.
North Carolina State Historic Preservation Office says between 1976, when the federal tax credit was initiated, to the end of 2020, there were more than 1,600 projects on incomeproducing historic structures representing an investment of almost $2.7 billion. “Many others are in progress right now,” says Myrick Howard, president of Preservation North Carolina, which helped the state develop the tax-credit program. “We pitched it as a pilot project just to see what would happen,” he says. “It went way beyond our expectations.”
Historic properties otherwise poised for the wrecking ball were granted new life as 21st century spaces for living, working, innovating, gathering and recreating. And the direct economic impact has been significant. Howard says rehabbing older buildings is more labor intensive than new construction. “[It] is a huge job producer, because it’s happening on the ground with local labor and local materials,” he says. “It’s not something you can turn into a commodity. That’s great from a jobs standpoint.”

FORMULA FOR SUCCESS
Few communities have more to show from the tax-credit program than Winston-Salem, whose Innovation Quarter has turned former R.J. Reynolds Tobacco Co. buildings into a cuttingedge collection for education, research and development, health care and urban living. Along Vine Street, factories No. 90 and No. 91 are now contemporary commercial buildings, modernized with the help of $350 million in tax credits. “Downtown WinstonSalem is unreal,” Howard says.
Originally called Piedmont Triad Research Park, Innovation Quarter grew out of Wake Forest Health Science’s need for additional research space in the early 2000s. After considering new construction on greenfield sites, leaders looked downtown. They began exploring opportunities for collaboration with Reynolds. The tobacco titan ultimately gifted its 40-acre properties, which aren’t far from where its headquarters still stands. “We started working on that in 2009,” says Graydon Pleasants, head of real-estate development at Innovation Quarter. While the Great Recession did little to further the effort, mill credits did. “We immediately rolled through every tax credit available,” he says. “And we focused on what we could do quickly.”
Innovation Quarter is a busy place. More than 3,600 people work at 90 companies and 1,800 students pursue a degree. Its partners include local governments and Winston-Salem’s five higher education institutions. Among the entities now involved with the venture is the Bowman Gray Center for Medical Education, which was completed in 2016. Renovated and developed by Baltimore-based Wexford Science + Technology, the 168,000-square-foot space includes tiered classrooms, a simulation-based instructional center, computer labs, study areas and dining space. The Bowman Gray Center is
Atriums, open spaces and an abundance of natural light create a welcoming look and feel while blending old with new. “There’s nothing like walking through these buildings,” Pleasants says. “It’s some pretty inspiring space.” Innovation Quarter has coworking space, fitness centers, loft apartments, coffee houses and office suites designed with startups in mind. Buildings are connected by 20 miles of greenways. The center of the Quarter’s community life is 1.6-acre Bailey Park. “It’s a highly programmed environment,” he says. In addition to standard park amenities, food trucks, live music and outdoor yoga classes are regularly scheduled. “It includes anything we can do to create a portal into the Innovation Quarter.”
Innovation Quarter has proven beneficial to the broader community and its efforts to create next-generation jobs in the one-time mecca of tobacco. Laura Johnson Lee, senior vice president at Greater Winston-Salem Inc., calls the property a “key asset” for the region’s economic development vision. “The impact of the Innovation Quarter is not limited to its property lines,” says Lee, who oversees business recruitment and retention for Forsyth County. “As one of the world’s leading innovation districts and the only development of its kind in North Carolina, it has come to represent a vibrant identity for Winston-Salem as a destination filled with creativity and innovation.”
Innovation Quarter’s success hasn’t gone unnoticed outside of the Triad. Winston-Salem-based Wake Forest Baptist Health announced it was joining Charlotte-based Atrium Health in October 2020. Atrium has plans for a large innovation district in its hometown that will include a new Wake Forest University medical school. Atrium is seeking $75 million from Mecklenburg County and the city, whose leaders toured Innovation Quarter in


Winston-Salem is reflected in windows of a building at Innovation Quarter. Bailey Park, right, is the center of social life at the mixed-use development.

was the world’s largest mill under one roof. An effort to organize its workers sparked a strike in 1929. Violence soon followed, which resulted in two deaths, including the city’s police chief. “It’s a very interesting history,” says Kristy Crisp, Gastonia’s economic development director.
Built in 1902, six-story Loray Mill had sat empty since it closed in the late 1980s. In 2013, renovations began, converting the 600,000-square-foot mill into a modern mixeduse community. Loray’s 189 loft apartments quickly drew takers, from young Charlotte professionals seeking affordable alternatives to Queen City real estate to empty-nesters hungry for low-maintenance living in a walkable downtown. The pandemic energized demand for the apartments. “There’s a waiting list,” Crisp says. “More people are rethinking office work for less dense environments.” She anticipates Loray’s 80,000
Urban Sports and Entertainment — FUSE — District, which has drawn attention from private developers. A lifelong resident of the community, Crisp is excited by the number of businesses and residents moving into the district. “When Loray was redeveloped, that was the kicker for a lot of what has happened since,” she says.
The FUSE District got a major boost in 2021, when CaroMont Health Park opened. The 5,000-seat multipurpose venue, which is six blocks from Loray Mill, is home to the Gastonia Honey Hunters, the newest Atlantic League of Professional Baseball team. City officials expect to offer family, music and entertainment events year-round at the park, which has indoor and outdoor banquet areas, a covered beer garden and 4,000-square-foot “Premium Club.”
Plenty is in play throughout the FUSE District. Casual and fine dining restaurants, along with a cigar and wine bar, are set to open. A boutique hotel is in the works, and coworking options should be available soon. Class A office space is part of the vision, too. Across the street from the stadium is Trenton Mill Lofts, an 89-unit residential environment cast inside an 1897 textile plant said to be the city’s second mill and oldest still standing. Florida-based Kaufman Lynn Construction is renovating the site, which will offer studio, one- and twobedroom apartments.

Crisp says FUSE is helping drive the local economy. “What has been rewarding is that private developers were and are interested in being close to it,” she says. Like Innovation Quarter, it includes important educational partners such as Belmont Abbey College and Gaston College, which are helping the community preserve the best of its textile-era past while forging ahead with plans for a diversified, connected local economy that draws residents, companies and investment capital. “Our goal is to get to that next level,” she says. “There’s great stuff happening here.”

READY TO WORK
Companies of all stripes choose the 12-county Charlotte region for many reasons. But workforce is one of the most important. An array of customized educational opportunities continuously improves and replenishes its pool of skilled workers, who enjoy an unmatched quality of life.
By Katherine Snow Smith
Arrival has big plans in the Charlotte region. The United Kingdom-based electric vehicle maker is building a $41 million factory at Meadow Oak Commerce Center in west Charlotte, not far from Charlotte Douglas International Airport. The delivery vans it will produce go about 150 miles between charges. Shipping and logistics provider UPS is buying 10,000 of them. And electric buses will be produced at its $46 million factory in Rock Hill, about 35 miles away in South Carolina. Both are expected to be up and running this year.
But these aren’t your typical assembly plants. Small in stature, Arrival’s “microfactories” source materials, build parts and sell their finished products locally. This reduces their environmental impact and makes them easily scalable — as many as 10,000 delivery vans or 1,000 buses annually with two shifts of workers — keeping pace with the surrounding region’s demand, the company claims.
Anthony Burton, principal researcher at Charlotte Regional Business Alliance, finds Arrival’s manufacturing model fascinating. “If they can’t find materials, they are going to make them,” he says. “They are having a vertical approach to the hardware and the software and the smart technology.” He expects businesses with similar goals and processes to follow, discovering how well the Charlotte region aligns with advanced manufacturing. Arrival plans to hire 150 people for its $3 million North
American headquarters in South End, the thriving business and residential district near Uptown Charlotte. It’ll be in good company. Charotte Regional Business Alliance says nine of the largest publicly traded companies and 18 of the 1,000 largest have headquarters within the 11 North Carolina and four South Carolina counties that it represents. They include financial giant Bank of America, home improvement retailer Lowe’s and Nucor, which makes steel and steel products. St. Louis-based managed-care provider Centene recently announced the first phase of its East Coast headquarters — 800,000 square feet of meeting and office space — in Charlotte. It’s expected to be complete this year. The second phase is expected to begin in 2024. It’ll push the campus to 2.4 million square feet and the employee headcount to 6,000.
Arrival CEO Mike Ableson says his company is a technology company at its heart. Many of the 250 workers at each microfactory will be engineers, writing and developing the software used to create parts and assemble vehicles. “We chose Charlotte as our U.S. headquarters for many reasons, including its East Coast location; a diverse, high-skilled workforce; government and corporate partners willing to partner on shared goals for future sustainability and equity; and the airport,” he says. “We look forward to growing in the Carolinas as we accelerate the transition to zero emissions vehicles.”

CHARLOTTE SNAPSHOT COUNTIES: City of
Alexander
Anson
Cabarrus
Catawba

Cleveland
Gaston
Iredell
Lincoln
Mecklenburg
Rowan
Stanly
Union
BIGGEST COLLEGES AND UNIVERSITIES
UNC Charlotte
Gardner-Webb University
Queens University
Central Piedmont Community College, multiple campuses
Rowan-Cabarrus Community College, multiple campuses
Gaston College, multiple campuses
ATTRACTIONS
U.S. National Whitewater Center, Charlotte
Charlotte Motor Speedway, Concord
Carolina Panthers NFL team, Charlotte
NASCAR Hall of Fame, Charlotte
Charlotte Hornets NBA team, Charlotte
Carowinds, Charlotte
Discovery Place, Charlotte
Daniel Stowe Botanical Gardens, Belmont
Schiele Museum of Natural History and Planetarium, Gastonia
N.C. Transportation Museum, Spencer
Lake Norman and Lake Wylie
INDUSTRIES
Business and financial services
Corporate headquarters
Aerospace and defense
Textiles
Energy
Automotive-parts manufacturing
As recently as two decades ago, the right site, low costs and a business-friendly community were the top reasons businesses cited for locating or expanding in the Charlotte region. While a talented workforce has always been important, it’s climbing that list. “Talent was in the top 10 or 15 in terms of a decision factor and what a company would want to know more about,” says Janet LaBar, Charlotte Regional Business Alliance president and CEO. “I think [a talented workforce] has been accelerated easily into the top three over the years. It’s about the first thing [businesses] ask about.”
A highly skilled workforce and the ability to train more people were key in landing Arrival. “This is kind of a dream project,” LaBar says. “Arrival sees the manufacturing strengths we have here that are very mature and established in the region.”
MUTUAL ATTRACTION
Catharine Pappas knows firsthand why companies choose the Charlotte region. She’s director of relocation and client services at Charlotte-based Dickens Mitchener Residential Real Estate, which has more than 115 agents, most of whom assist in relocations. Some are working to find homes for Arrival employees. “North Carolina is a huge draw because of our low
corporate tax rate,” she says. “Charlotte checks all the boxes. We have local talent on the ground. We have amazing universities. UNC Charlotte has one of the top business schools in North Carolina. Central Piedmont Community College is one of the best community colleges around.”
Pappas says there’s plenty more to attract businesses. “Our airport is amazing,” she says. “Most companies can get to 90% of their clients within two hours from Charlotte. The less time your workforce is in the air the better. We have clients who live in Charlotte and commute to New York every week because it’s so easy and much less expensive than living there.”
While numbers have fluctuated during the COVID-19 pandemic, Charlotte Douglas International Airport averages 700 flights a day and offers nonstop service to 145 cities, including 33 international destinations, according to the Charlotte Regional Business Alliance. Pappas helped relocate employees from a company moving to Charlotte from Austin, Texas, a couple years ago. She says the main reason they left was that visiting a client meant two days dedicated to travel.
Employees of these companies are happy to relocate to the Charlotte region, too. Pappas says they account for about 25% of closings at Dickens Mitchener each year. “They love the quality of life,” she says. “They love our weather. Charlotte has national

sports teams and over 56 miles of developed greenway trails. You can find live music most nights of the week. The U.S. National Whitewater Center offers year-round recreational activities. All of these things make Charlotte hot on everybody’s list.”
The pandemic magnified the importance of loving where you live. “Clients want their home to be their sanctuary,” Pappas says. “It’s not just an investment or a place to sleep. People are ready for the quality of life we have here. They want a yard. They want a place to entertain.”
Wherever a company relocates or expands in the Char lotte region, its employees have housing options. Charlotte, for example, offers stately homes shaded by large oaks, craftsman bungalows on brick streets, and downtown condominiums and apartments. Seven in 10 people moving to the Charlotte region ended up in Mecklenburg County in 2011. But by 2019, it was the destination of only three in 10. Wide-open spaces, new housing developments and small-town living is less than an hour away in any direction of Uptown. That includes Belmont in Gaston County. “Belmont has an adorable, quaint downtown,” Pappas says. “It’s about a 15- to 20-minute commute to Uptown Charlotte on Interstate 85.”

of traveling by light rail. Charlotte Area Transit System has proposed adding the 29-mile Silver Line to its LYNX light-rail system under its 2030 plan. It would run from Belmont through Charlotte’s center to Matthews in Union County. Its 29 stops would include the airport, Truist Ballpark, home to Triple A baseball team Charlotte Knights, Bank of America Stadium, home to the NFL’s Carolina Panthers, community college campuses and hospitals.
Many commuters drive to Charlotte for work. But within the next decade, plans call for more of them to have the option
CATS currently operates two rail lines. Its 4-mile CityLYNX Gold Line offers streetcar service to 17 stops from the historic

Belmont is home to the 380-acre Daniel Stowe Botanical Garden, a destination for spectacular gardens, sparkling fountains, a conservatory, a garden store and nature trails.
West End through Center City to the Elizabeth Neighborhood. Its service length and number of stops will more than double under the 2030 plan. “The Gold Line that goes through Uptown to Johnson C. Smith [University] has really opened up Biddleville [neighborhood],” Pappas says. “There’s charming craftsman style housing as well as some new construction.”
The nearly 19-mile LYNX Blue Line connects South Boulevard at Interstate 485 and UNC Charlotte’s main campus. It’s about a 45-minute ride from end to end and has 26 stations and 11 park-and-ride locations. CATS also has proposed a Red Line as part of its 2030 plan. It would connect northern suburbs, including Davidson, Huntersville and Cornelius, with Charlotte.
The LYNX system’s Blue Line stops in South End, where Arrival’s headquarters will open. LaBar says Charlotte’s light rail was a big draw for the company. The neighborhood is exploding with new housing and businesses. From an eBike store to numerous restaurants and loft apartments to hip night life, it’s attracting thousands of new patrons and residents from ages 18 to 30.


Charlotte’s light rail line



The U.S. National Whitewater Center
TRAINING TOMORROW’S WORKERS
Manufacturers aren’t the only ones hiring workers with tech skills. Centene’s North Carolina operations, for example, have hired about 900 employees. About 60% of them are in Charlotte, according to a Centene spokesperson. They have a breadth of duties, including information technology and business analytics. And commercial banking, which Charlotte Regional Business Alliance says accounted for about 42,000 jobs with an average salary of $156,000 in 2020, has been developing technology before many other business sectors. “Over the past 10 years, they really have ramped up the amount of tech talent they are hiring,” Burton says. “Several tech centers have located in Char lotte over the past few years. Since financial institutions were really ramping up their tech talent, and there was a critical mass and [other tech companies] wanted to take advantage of that.”

While the talent and potential of the Charlotte region’s workforce is an important consideration today, employers know their workforce needs will be different tomorrow. The Charlotte region is ready to meet those, too. “When it comes to being able to prove what our skilled and educated workforce looks like, we have so much to offer because of the saturation of higher education institutions,” LaBar says. Twenty-five research universities are within 200 miles of Charlotte. Schools within the region produce 15,000 graduates a year.
North Carolina is known for its strong system of community colleges, which work closely with industry to customize workforce training programs that teach in-demand skills. Burton pointed to Catawba Valley Community College in Hickory. Its

84,000-square-foot Workforce Solutions Complex, for example, has classrooms and labs where students learn advanced manufacturing and tech skills that are needed in today’s workplace.
Apprenticeships are a time-tested means of workforce training. At Gaston College, for example, Apprenticeship 321 brings together local employers and students, who receive job-specific training while working alongside mentors without paying tuition and earning a paycheck. Registered with ApprencticeshipNC and U.S. Department of Labor, the program also offers graduates nationally recognized certifications, college credits and a National Career Readiness Certificate.
The Charlotte region’s educational profile got a big boost when Atrium Health, Wake Forest Baptist Health and Wake Forest School of Medicine announced they were creating a fouryear medical school, Charlotte’s first. Construction at the 20-acre site, less than 1 mile from Atrium’s Carolina Medical Center, is expected to begin early this year. “We have a great blend of both institutions and programs that are getting folks skilled in a variety of disciplines,” LaBar says. “We are also well positioned to import talent as well. People always want to migrate to the Charlotte region.”
A Catawba Valley Community College student tufts a piece of furniture.


POWER OF ATTRACTION
Eastern North Carolina has a thriving solar energy sector, among other attributes. Now a similar passion is building for developing wind and other alternative energy sources, aided by the region’s ample supply of land and workers.
By Kathy Blake and Teri Saylor
Amy Braswell has a unique perspective on building prosperity in her community. In addition to managing her family’s 600-acre farm in Hertford County, she is Ahoskie Chamber of Commerce’s executive vice president, recruiting businesses, industry and jobs.
Lately, Braswell’s focus is on renewable energy. And in December 2020, when she accepted a North Carolina Clean Energy Champion award from San Francisco-based Chambers for Innovation and Clean Energy, she expressed optimism that renewables would spur further economic growth. “Hertford County is a mix of industries and agriculture, and we are now adding renewable energy to our portfolio,” she said during the ceremony. “We see the opportunity, and we are absolutely certain that renewables will play a role in our future economic development planning.”
Hertford County abuts Virginia and the Chowan River in northeastern North Carolina. It’s home to 13 solar farms, including one of the state’s largest. Developed by Mooresvillebased SunEnergy1, its 400,000 panels can generate 80 megawatts of electricity, enough to power about 20,000 homes. And more are on the way to the county. Contracts and permits are in place to construct three solar farms, including one along U.S. 158, outside of Murfreesboro.
While Hertford County commissioners temporarily paused solar farm development last year to study them and implement some control, Braswell, whose farm is almost within sight of the largest one, sees renewable-energy generation as an opportunity. “When you improve quality of life, you can attract more people and businesses, and it is a win-win for us in every direction,” she says. “A lot of people think of eastern North Carolina as being just an agricultural economy, but here in Hertford County, we continue to stay focused on growing our industrial base while contributing toward the state’s clean energy goals.”
As North Carolina races toward Gov. Roy Cooper’s goal of a 40% reduction in greenhouse-gas emissions by 2025, its leaders are counting on energy initiatives to protect the health and prosperity of its residents, create jobs and modernize power generation. By leveraging energy resources, innovative public- and private-sector partners, and a competitive workforce, the state is positioned to drive a far-reaching transition to a clean-energy economy. But wielding these assets must be done while keeping energy prices affordable and maintaining North Carolina’s business climate, which Site Selection magazine ranked the nation’s best in 2021.
Knoxville, Tennessee-based Southern Alliance for Clean Energy, which champions energy choices that strengthen
Wilmington
EASTERN SNAPSHOT

COUNTIES:
Beaufort
Bertie
Bladen
Brunswick
Camden
Carteret
Chowan
Columbus
Craven
Cumberland
Currituck

Dare
Duplin
Edgecombe
Gates
Greene
Halifax
Hertford
Hoke
Hyde
Jones
Lenoir
Martin
Montgomery
Nash
New Hanover
Northampton
Onslow
Pamlico
Pasquotank
Perquimans
Pender
Pitt
Richmond
Robeson
Sampson
Scotland
Tyrrell
Washington
Wayne
Wilson
BIGGEST COLLEGES AND UNIVERSITIES
East Carolina University, Greenville
UNC Wilmington
UNC Pembroke
Fayetteville State University
Fayetteville Tech Community College
Cape Fear Community College
Pitt Community College
ATTRACTIONS
Cape Hatteras Lighthouse and Wright
Brothers Memorial, the Outer Banks
Historic Tryon Palace, New Bern
Battleship North Carolina, Wilmington
Airlie Gardens, Wilmington
1886 Roanoke River Lighthouse, Edenton
North Carolina Aquariums: Kure Beach, Roanoke Island, Nags Head and Pine
Knoll Shores
Fort Fisher State Historic Site, Kure Beach
N.C. Maritime Museums: Beaufort, Hatteras, Southport
INDUSTRIES
Aerospace and defense
Agriculture
Biotechnology
Marine trades
Metalworking
Textiles
Tourism

communities, calls North Carolina “the undisputed leader in solar-energy development and deployment in the Southeast.” In 1975, the General Assembly passed the North Carolina Energy Policy Act, recognizing the development of a reliable and adequate energy supply that is secure, stable and predictable is in the state’s best interest — pushing economic growth, creating jobs, and expanding business and industry. That’s helped attract large data centers, including one for Apple in Catawba County and one for Google in Caldwell County. Many companies have mandates that call for reducing their carbon footprint. Using renewable energy helps meet those.
Clean energy is an emerging industry with a great deal of potential for North Carolina, says state Commerce Sec. Machelle Sanders, the 30-year pharmaceutical and biotechnology executive who was appointed in February 2021. “North Carolina has one of the best natural resources off our coast for that industry, and when combined with the industrial base that’s located here, the upside can be significant for us,” she says. “We commissioned a study earlier this year that showed a market potential in the U.S. of more than $100 billion from offshore wind. Gov. Cooper’s Executive Order 80 lays a framework the state can follow that could help North Carolina capture a significant portion of this opportunity, along with other areas in the emerging clean energy economy. North Carolina deserves its fair share of this more than $100 billion economy.”
As a member of Chambers of Innovation and Clean Energy, Ahoskie Chamber of Commerce is part of a nationwide network that helps its more than 1,000 members navigate and prosper in the clean-energy sector. CICE has named North Carolina as one
of its priority clean-energy states in part because it’s second in the nation for installed solar capacity and ninth for clean-energy jobs. The organization also recognizes the state’s $120 million in renewable energy grants, more than 8,000 solar and wind energy jobs, and $9 billion in solar and wind capital investment.
Braswell touts wind-energy development in northeastern North Carolina. Amazon Wind Farm North Carolina – Desert Wind, the first coastal wind farm in the Southeast, sits on land leased from 60 landowners in Perquimans and Pasquotank counties. Its 104 high-tech turbines, which can generate 208 megawatts of energy, enough to power 61,000 homes, reached full commercial operation in 2017. Portland-based Avangrid Renewables, a subsidiary of Orange, Connecticut-based Avangrid, which has renewable energy projects and 6,500 employees across 22 states, developed the project, which generates more than $1 million in annual county tax revenue and lease payments.
Avangrid Renewables’ work in northeastern North Carolina isn’t finished. It submitted a construction and operations plan to the federal Bureau of Ocean Energy Management in December 2020 for the first phase of the Kitty Hawk Offshore Wind Project, which will be located about 27 miles offshore of Corolla, a popular spot for tourists and wild horses on the Outer Banks. It will cover almost 122,500 acres and is projected to generate about 2,500 megawatts of electricity, enough to power about 700,000 homes.
Susan Munroe, who works from Raleigh as CICE’s director of economic development, calls the Kitty Hawk project exciting. She believes it will bring hundreds of jobs and millions of dollars in investment. “It’s the supply chain opportunity that is going to create the magic,” she says. Nucor’s Hertford County steel-plate
Eastern North Carolina is home to the Outer Banks and the Cape Hatteras lighthouse. It also has a booming renewable energy industry built on solar and wind power.
mill in Cofield, for example, could be a link. And Sanford-based SpanSet supplies pieces that lift components as offshore projects are built in place. Local chambers, such as Ahoskie, are perfect facilitators for county economic-development initiatives. “They’re the driving force in attracting business, industry and special projects, like solar and wind farms, to their communities,” she says.
Offshore wind generation is expected to provide more than 36 gigawatts of power — enough to power more than 9 million homes — over the next decade. Steve Kalland, executive director of N.C. Clean Energy Technology Center at N.C. State University, says that will require billions of dollars of investment. North Carolina is poised for the opportunity. “We are one of the more manufacturing friendly states, so there is a real push to work, to set North Carolina up to capture supply chain jobs out of offshore wind projects,” he says. There’s no time to waste. Other states are pursuing these opportunities. “When it comes to competition, the race to deliver clean energy and a greener, more modern utility grid will pay off in economic development,” he says.
North Carolina already has made strides in developing solar energy. So, the Clean Energy Technology Center, which works
to grow the sustainable energy economy, and Commerce are collaborating, studying potential economic growth, as well as supply chain and workforce opportunities, that could come with the expanding East Coast offshore wind energy industry. “We’ve certainly seen a lot of job creation from the solar boom in North Carolina,” Kalland says. “And now we have a chance to become a player for offshore wind construction and deployment, particularly for the projects that will be off our coast.”
Commerce recently started the North Carolina Offshore Wind Supply Chain Registry, which allows companies to publicly declare their interest and ability to supply wind-energy projects with components and services. Those include blades, towers, cables and wind-turbine parts, along with the infrastructure to bring power ashore. Transport and assembly of components, construction staging and site-related work also create jobs. And with ports in Morehead City and Wilmington, North Carolina’s coast offers opportunities to facilitate construction on shore and on the water.
Plugging into offshore wind power won’t be without challenges. Kalland foresees the biggest coming from reaching

a consensus among policy, politics, business and industry about the best strategy to facilitate these changes in energy resources. “If we take too long deciding what we should do, or if we are not expansive enough in our thinking, we run the risk of falling behind neighboring states and other regions of the country that are working with some urgency on these issues,” he says. “If we do it right, we’ll continue to be a leader. And if we don’t, then we’ll be labeled a follower.”
Raleigh-based North Carolina Electric Cooperatives represents 26 not-for-profit electric cooperatives, which serve about 2.5 million residents across an area that’s equal to nearly half of the state. Nelle Hotchkiss, the organization’s chief operating officer and senior vice president of association services, says over the last five years, contributions to more than 100 economic-development projects have created more than 5,000 jobs and more than $1 billion in capital investment in rural North Carolina.
Among the cooperatives’ priorities are providing sustainable energy at the lowest possible cost, innovating and advancing grid operations, continuing emphasis on reliability and resilience, and encouraging community support. Hotchkiss says they developed an initiative that aligns with the state’s Clean Energy Plan, which calls for carbon neutrality by 2050. “Our Brighter Future vision focuses on creating a low-carbon environment through sustainability and investment in low-to-zero emissions energy sources but also through integrating innovative technology that makes the electric grid more resilient, robust and flexible,” she says. “We continue to invest in power sources such as nuclear,
which is carbon-emissions free, and natural gas, and we are increasing our use of renewable resources, including solar.”
The cooperatives have five microgrids in operation or under development. They add resiliency, sustainability and efficiency. The cooperatives also are expanding battery storage applications and investing in system redundancies to increase grid resilience and help move renewable energy to wherever it’s needed. “The state’s electric cooperatives are proud to play a central role in keeping our state on the leading edge of a forward-thinking energy policy discussion,” Hotchkiss says.
Eastern North Carolina’s attraction may start with energy. But there’s more, and people are noticing. In five years, real-estate agent Kris Vick predicts business and population growth will turn Currituck County, for example, “into a mini-Norfolk [Virginia], actually.” Its population is expected to grow to more than 40,000 by 2035, and it has already increased by 18.7% in the last decade. And from 2015 to 2020, jobs increased by 9.1%.
Some of the region’s growth is poised to happen next to 29,000-student East Carolina University in Greenville. Chancellor Philip Rogers is overseeing Intersect East, an eight-year plan that blurs the boundary between campus and downtown. Formerly the Warehouse District because of its historic Export Leaf Tobacco and American Tobacco Co. buildings, its 19 acres are adjacent to ECU’s main campus and will have two 60-unit apartment complexes, office and research space, restaurants and parking for young professionals and students; a high-tech research and innovation hub; and a hiking-biking trail by 2027, when

East Carolina University in Greenville is transforming former tobacco warehouses into apartments, office and research space, and restaurants. The Intersect East project is expected to be complete by 2027.
construction is expected to be complete. It’s projected to create 1,500 jobs and $3 million in annual tax revenue.
Filling those jobs and others in the region’s growing energy, biotechnology and manufacturing sectors requires a cooperative effort. Kelly Andrews, Pitt County Economic Development executive director, says Pitt’s workforcedevelopment plan involves the county, Pitt Community College, ECU, Pitt County Schools and N.C. Biotech Center. Sec. Sanders has focused Commerce’s economic development strategic plan on the issue, unveiling First in Talent to keep the state’s workforce among the nation’s best.
Rocky Mount-based Carolinas Gateway Partnership President and CEO Norris Tolson says rural eastern North Carolina has one more advantage — plenty of reasonably priced land. “You can buy a decent plot of land in Edgecombe for $20,000 that in Charlotte would cost you $100,000,” he says. “You can still get good property in Nash and Wilson [counties] and elsewhere. The saying is ‘location, location, location.’ But we like to say, ‘ready, ready, ready.’ If you want to continue to grow and prosper, you better have a major stake in the U.S., because a lot of major companies are moving their supply chains back, instead of Asia or someplace else. And when they come back onshore, you better be ready. If you’re not — if you don’t have the land, the workforce, the buildings, all those things — they’ll move on down the road.”



INSIDE JOB
Logistics, location and labor have been key factors in the Triad’s economic success. Investments are ensuring continued growth throughout the Carolina Core.
By Kathy Blake
The Triad is named for the geometric arrangement of its most populous cities — Greensboro, Winston-Salem and High Point. But there’s more to the 12-county region than its moniker. It’s home to three interstates with two more under construction. More than 110,000 students are enrolled in Triad colleges, universities and technical schools. And its diverse economy includes aviation and aerospace, logistics, entrepreneurship and biotechnology sectors.
Adjoining the Triad is the Carolina Core, a 120-mile swath that starts west of Winston-Salem and continues toward Fayetteville, following the route of U.S. 421, which is the future Interstate 685. It boasts six industrial parks, including one at Piedmont Triad International Airport and two megasites. Thousands of shovelready acres are positioned so eventual tenants can take advantage of customizable workforce development, distribution routes and growing consumer markets.
Stan Kelly, who will be turning over the CEO reins of Greensborobased Piedmont Triad Partnership to its president, Mike Fox, in May, says the Carolina Core brand launched three years ago. “We are working to further strengthen our region and market the physical assets of the Core as well as its sector strengths and talent advantages,” he says. “We are a region that has invested in itself. To date, the public and private sectors have invested hundreds of millions of dollars in infrastructure, building sites and higher education, which will support economic growth in the Carolina Core for years to come.”
Penny Whiteheart, the partnership’s executive vice president, calls Carolina Core’s momentum “the new economy” with regional supply chains, reshored manufacturing and a local industrial focus. “Stan [Kelly] has said time and again that our region believes in the notion that a win for one is a win for all,” she says. “A win for one community benefits not only that community but the surrounding region and the entire state. The Carolina Core’s economic momentum is fueled by its unique combination of assets, from megasites to Class A office space, from bustling metros to rural communities. Leaders from the Carolina Core are closely aligned with my administration and [the Economic Development Partnership of North Carolina]. We have worked together to recruit industry to the state, to support efforts to make [U.S.] 421 a future interstate and to support our higher education institutions, among other initiatives.”
PARK IT
Bob Leak is a more than 30-year veteran of economic booster Winston-Salem Business Inc., which joined forces with the Winston-Salem Chamber of Commerce to form Greater Winston-Salem Inc. in 2019. He was named Whitaker Park Development Authority president in March 2020. Though the past year has proved challenging with the COVID-19 pandemic and stay-at-home orders, he sailed forward, using marketing,

TRIAD SNAPSHOT
COUNTIES:
Alamance
Caswell
Davidson

Davie Forsyth Guilford Montgomery
Randolph
Rockingham
Stokes
Surry
Yadkin
BIGGEST COLLEGES AND UNIVERSITIES
UNC Greensboro
Wake Forest University, Winston-Salem
Elon University
High Point University
N.C. A&T State University, Greensboro
Winston-Salem State University
Guilford Technical Community College, multiple campuses
Forsyth Technical Community College, multiple campuses
ATTRACTIONS
North Carolina Zoo, Asheboro
International Civil Rights Center & Museum, Greensboro
Old Salem Museum & Gardens, Winston-Salem
Greensboro Science Center, Greensboro
Andy Griffith Museum, Mount Airy
Yadkin Valley Wine Country, Elkin
Kaleideum Science and Children’s
Museums, Winston-Salem
INDUSTRIES
Aerospace and defense
Furniture
Finance
Insurance
Textiles
Winemaking
Downtown Greensboro
videos and website updates to promote what he’d been coaxing from backstage for two years. “[It was] like trying to sell real estate from the upstairs bedroom,” he says. “We had projects that were underway, and we were able to host the occasional visitor, put our masks on and knock on wood.”
Winston-Salem-based tobacco company Reynolds American donated 220 acres for the park. “It’s an industrial area and has been since Reynolds developed it in the ‘60s,” Leak says. “Our goal is to re-energize this facility and this property into industrial and distribution and residential and hotel space and bring some vibrancy to the surrounding area.”
Whitaker Park is 2 miles north of downtown Winston-Salem and adjacent to Wake Forest University. It has rail access and is a half-hour drive from PTI. Using phrases such as “economic catalyst” and “banner year,” Leak doesn’t waiver on the park’s promise, which is already showing. Bloomington, Ind.-based Cook Medical, for example, will use an 850,000-square-foot former cigarette factory — at one time the world’s largest — to make medical devices. Its 650 Winston-Salem-based employees will work there, along with 50 more by 2030. The park’s original tenant, Raleigh-based Virtue Labs, has doubled its space for manufacturing hair products, and a mixed-use development that includes 300 apartments, a hotel and retail space was announced in 2019.
Leak says the past year has reaffirmed his belief in the park’s potential. “We have three projects under contract, and we closed on the residential in December [2019],” he says. “I think in five years, it will be the catalyst we anticipated it would be. When we got this park, it was all empty. We’re trying to recruit companies that will put a lot of people back to work, increase the tax base of the community, and support the Wake Forest [University] campus and the athletic campus: large-scale projects that will have an impact.”
Carolina Core’s growth is both organic and cultivated. “I think there’s no question [that] this is a new dynamic, but it’s not the
only piece of the puzzle,” Leak says. “For instance, two projects we’re looking at right now are wanting to relocate because they’re looking at a better cost of operations, a better quality of life, access to highways and ports. So, we continue to have interest from out of the area. But there’s no question that future growth in the Triad will come from entrepreneurship and startups. You have to do some recruiting. To be successful, you have to take the holistic approach to make communities better.”
TAKING OFF
Carolina Core’s higher-education offerings include Jamestownbased Guilford Technical Community College. It’s a gateway to jobs at PTI, where aviation-related companies, such as aircraft refurbisher HAECO Americas and delivery company FedEx, have set up shop. Nick Yale, the college’s director of aviation programs, has worked in the aviation industry for 30 years, including stints as a technician, instructor, private pilot, airframe and power-plant technician, and avionics technician. “We have one goal, which is to offer successful programs where upon completion, students can and will be hired by local, regional or national aviation employers,” he says. “We have successful apprenticeships set up with multiple employers in the region, so students can be gaining real experience while they are in classes.”
Guilford Tech’s Aviation Campus at PTI includes three buildings. The T.H. Davis Aviation Center — also known as Aviation I — opened in 1989, was renovated in 2016, and houses a helicopter, eight aircraft and 20 training systems. Aviation II is a 60,000-square-foot building with seven classrooms and 14 specialty labs that serves about 100 students daily in avionics, Aviation Manufacturing Quick Careers Program, and sheet metal and composites, the modern materials that today’s aircrafts are made of. The Caesar Cone II Aviation Building — also called Aviation

Students gain hands-on experience in aviation manufacturing at Guilford Technical Community College.
III — opened in 2014 on 20 acres and is home to the aviation management and career pilot programs.
Guilford Tech recently added an aerospace manufacturing technology course and has three specialist tracks. Yale says the continuing education department is growing, too, adding classes in nondestructive testing and composites. “We are working on additions for commercial drone licensing and utilization,” he says. “And we are also working on the expansion of drone training to support the survey industry and marry up our offerings with our civil-engineering program with a transfer degree to [North Carolina Agricultural and Technical State University].”
Jobs are waiting for graduates of Guilford Tech’s aviation program.
“HAECO has created a new website — HAECOisHiring.com — to help educate and guide those interested in a career with HAECO, as well as a longstanding training partnership with Guilford Technical Community College,” HAECO Airframe Services President Bill Collins said in a release. “We are committed to creating a career path for people who want to grow into these jobs.”
Yale says HAECO’s growing demand for workers stems from contracts that kicked off last summer. But it’s not the only company that’s interested in Guilford Tech’s students, even before they’ve earned a degree. “GTCC has an apprenticeship with HAECO set up in aviation, and about 40 to 50 apprentices are involved at one time,” he says. “HAECO is looking for more. We also are trying to expand our regional aviation business, specifically Signature TechnicAir, Textron[-owned] Cessna, Honda, DaVinci Aerospace and Sky Aircraft Maintenance. We are applying for grants to support this expansion [and] hope to add another 20 to 30 apprentices in fall 2021. Delta Airlines and Endeavor Air in Raleigh also are recruiting at the school.”


Honda Aircraft’s HondaJet Elite S, made in Greensboro, was one of the “Coolest Things Made in North Carolina” on the 2021 N.C. Chamber list.
SITES TO SEE
Kelly can list all the reasons that make the region attractive to businesses. But he’d rather have them do it. “Companies have cited the Carolina Core’s robust workforce, strategic location, vast transportation and logistics networks, readily available sites and excellent quality of life as reasons to invest in the Core,” he says. “From our companies to our people to our deep investments in our communities, the Core is defining itself as a future-ready region brimming with opportunity set to transform North Carolina.”
The Carolina Core’s strongest sector is advanced manufacturing. “That is where our history is and where we see our future,” Kelly says. Recent economic development proves his point, with Nestle Purina PetCare’s $450 million investment that will bring 300 jobs to Rockingham County and furniture-maker Prepac Manufacturing’s $27 million investment and 200 jobs in Guilford County.
Carolina Core is dotted with industrial sites, railway connections and colleges. “Related to manufacturing is our logistics and transportation infrastructure,” Kelly says. It’s a selling point. Atlanta-based fast-food chain Chick-fil-A, for example, is building a $52 million distribution center that will create 160 jobs in Mebane, and United Parcel Service, also based in Atlanta, is investing $316 million and adding nearly 600 jobs to its delivery efforts in Mebane, Graham and Greensboro.
Industrial site opportunities are available for almost any need. The largest can be handled at Carolina Core’s two megasites. The Greensboro-Randolph Megasite’s 1,825 acres is near interstates 40 and 85. And Chatham-Siler City Advanced Manufacturing Site’s 1,802 shovel-ready acres is about 50 miles from two international airports, Piedmont Triad and Raleigh-Durham International.
Smaller-scale expansions and startups will find 10- to 1,000acre sites at Triangle Innovation Point, which is billed as a life-

sciences and advanced-manufacturing industrial park. And PTI Aerospace Center has 1,000 acres ready for development and proximity to Guilford Tech’s workforce training and graduates.
INNOVATIONS AND MOTIVATIONS
Collaboration is charting Carolina Core’s course. “Public and private leadership … is highly engaged and aligned on a vision for the future,” Whiteheart says. “The very formation of the Core is a result of regional partners coalescing around the area’s competitive assets to tell a story. From Winston-Salem’s Innovation Quarter, one of the nation’s foremost urban research parks, to Greensboro’s [Steven] Tanger Center for the Performing Arts, to High Point’s downtown catalyst project … community leaders have rallied around transformational projects for the good of the entire region.”
Innovation Quarter is marketed as a “knowledge community” for its transformation of an industrial district into a mixed-use collection of 1,000 apartments and lofts, retail — coffee shops, salons, financial services and restaurants — 20 miles of greenway and office space for 90 companies. It was recognized in December 2020 as “Best Practice for Creating Integrated Places” by research group Global Institute on Innovation Districts, which estimates that more than 100 are emerging worldwide, mixing workers, businesses, extracurricular activities, and research and development.
Innovation Quarter has 28 acres of shovel-ready land for development, but it’s not the only place where Carolina Core’s entrepreneurial spirit thrives. Congdon Yards in High Point has studio units suited for startups and small businesses, and private office and full-floor suites. A common area, boardroom, coffee bar and courtyard foster collaborations. A former textile mill, The Gateway building in Greensboro offers build-to-suit offices for entrepreneurs. “The Core is undergoing multi-billion-dollar downtown transformations to revitalize and repurpose downtown cores into mixed-use and residential living space to breathe life into downtown centers,” Kelly says.
Part of that transformation comes from a COVID side effect: Many people are looking to relocate, escaping crowded urban centers to work remotely. “We believe that midsized cities are extremely attractive to people growing their career,” Kelly says. “In the Core, businesses and people can access North Carolina’s fastgrowing metros while still benefiting from the perks and quality of life of midsize cities and small towns.”
Even as vaccinations put pandemic restrictions in the rearview mirror, Carolina Core will continue to drive ahead. “We look forward to continuing our work together to win new jobs and expansions in the Core,” Whiteheart says. “Together, we can secure a strong future for generations to come and ensure North Carolina is among the most prosperous and competitive states in America.”
Innovation Quarter in Winston-Salem


PLUGGED IN
Technology companies — from startups to global players — are attracted to North Carolina’s Triangle region. Its combination of research, skilled workforce and quality of life has made it one of the nation’s fastest-growing metro areas.
By Katherine Snow Smith
Apple’s eye has long been on North Carolina. The Cupertino, Calif.-based technology giant, whose iPhones and other inventions regularly change how we communicate and recreate, has a presence in the state. It always seems to be in the running for Apple’s expansions, and it won a big one in April 2021.
Two years after Apple chose Austin, Texas, over North Carolina and a handful of other sites for a $900 million corporate campus, it selected a corner of Research Triangle Park near Cary and Morrisville for a massive 1 million square foot research and development, operations and engineering hub. Part of a $1 billion investment statewide by 2032, it will only use renewable energy and create 3,000 jobs with an average salary of more than $187,000 in Wake County, where the current average annual wage is almost $64,000. If the company meets performance milestones, the state’s Job Development Investment Grant program will reimburse it about $845 million of the almost $2 billion in new tax revenue over 39 years.
The move was a homecoming for Apple’s chief operating officer, Jeff Williams. “As a North-Carolina native, I’m thrilled Apple is expanding and creating new long-term job opportunities in the community I grew up in,” he said at the announcement. “We’re proud that this new investment will also be supporting education and critical infrastructure projects
across the state. Apple has been a part of North Carolina for nearly two decades, and we’re looking forward to continuing to grow and a bright future ahead.”
Apple’s investment includes more than $100 million to support schools, economic development and community initiatives statewide. It will retain its 1,100 employees already working in North Carolina. Some of them are in Catawba County, where it will spend about $450 million to expand a data center over the next decade.
Apple’s latest commitment joins Google’s recent announcement of 1,000 jobs at a Durham engineering hub, part of a $7 billion investment nationwide, and Redmond, Wash.-based Microsoft’s $47.5 million investment in Morrisville, not far from Raleigh-Durham International Airport, where it’s adding 500 workers, mostly software engineers and developers. And those are on top of the region’s growing biotechnology sector. None of them are truly a surprise. The Triangle, anchored by Raleigh, Durham and Chapel Hill, always has been a technology hotbed. It’s home to the first $1 billion open-source software company — Red Hat — which operates as an independent subsidiary of IBM, and Epic Games, creator of the ubiquitous “Fortnite,” which has more than 350 million registered users. But there always is room for more.

BIGGEST COLLEGES AND UNIVERSITIES
N.C. State University, Raleigh
N.C. Central University, Durham
UNC Chapel Hill
Duke University, Durham
Wake Technical Community College, multiple campuses
Central Carolina Community College, multiple campuses
ATTRACTIONS
North Carolina Museum of Natural Sciences, Raleigh
PNC Arena, home of NHL’s Carolina Hurricanes and N.C. State basketball, Raleigh
State Farmers Market, Raleigh
COUNTIES:

Granville Harnett
North Carolina Museum of Art, Raleigh
Durham Performing Arts Center
Morehead Planetarium and Science Center, Chapel Hill
Marbles Kids Museum, Raleigh
North Carolina Museum of History, Raleigh
Museum of Life and Science, Durham
Koka Booth Amphitheater, Cary
INDUSTRIES
Biotechnology and pharmaceuticals
Information technology
Clean technology
Higher education
State government
Christopher Chung, CEO of the Economic Development Partnership of North Carolina, the public-private effort that recruits businesses, helps current ones expand and promotes tourism, says Apple’s globally recognized name and size of its latest commitment will help it market the state as the place to start, relocate or expand a technology business. “We expect other businesses — particularly in Silicon Valley and even globally — to take notice of this major announcement,” he says. “And that will definitely boost our future recruitment efforts.”
And it’s not only about relocations or expansions by big tech companies. Apple’s project will make way for more startups, too. “When Apple puts such a major presence here it’s saying something about the fertility of the technology ecosystem,” Chung says. “That is a supreme vote of confidence in the business climate, in the availability of talent and how [Apple] sees this place as a location to recruit people who don’t live here today. They really need to be assured the local community is providing a good talent pool to draw from. They also have to be convinced if they are making an offer to someone moving from Boston or Silicon Valley or Austin, this is an attractive place for someone to move with his or her family or on their own.”
Technology companies find many reasons to start, relocate or expand in North Carolina’s Triangle region. Michael Haley, executive director of Wake County Economic Development, points to four that he believes attracted Apple: talent, diverse regional economy, quality of life and educational ecosystem. “Our three tier-one research universities … they are a distinguishing factor,” he says. “We also have three [Historically Black Colleges and Universities] with N.C. Central University in Durham and Shaw University and St. Augustine University in Raleigh.”
The Triangle region takes its name from the geographical relationship of its three esteemed research universities and their hometowns: N.C. State University in Raleigh, University of North Carolina in Chapel Hill and Duke University in Durham, where Apple CEO Tim Cook earned his master’s degree in business administration. The proximity of those schools also laid the foundation for Research Triangle Park in 1959. It has grown to become the country’s largest research park — 7,000 acres.
The close concentration of three HBCUs was important to Apple, too. “It was something we emphasized on a state and local level as part of the pitch,” Chung says. “Technology companies recognize they have some work to do when it comes to diversity

of their workforce. This has really come to light in the last few years. Companies like Apple are very interested in developing relationships with HBCUs.”
Workforce development, customized to the needs of each company, is a hallmark of the 58-campus North Carolina Community College System. Its largest — Wake Technical Community College — is serving the workforce training needs of technology companies with its 94-acre RTP campus, which opened in 2018 and will eventually have an enrollment capacity of 7,000 students. It already offers a variety of programs, including cybersecurity, business analytics, data storage and virtualization, and network management. Students can use these skills to land jobs or as the foundation for further study, either earning an associate degree at Wake Tech or transferring to a college or university for a four-year degree.
Cisco Systems, Lenovo Data Center Group, AT&T and Fidelity Investments donated a combined more than $500,000 for equipment, technology and scholarships at the RTP campus. Lenovo, for example, has an average of 20 Wake Tech students in paid work-based learning programs at a time. And in the past two years, 25% of them have become full-time employees upon graduation. “That RTP campus is precisely focused on the disciplines and training in the [information-technology] space such as cybersecurity,” Haley says. “It’s designed so that employers and the school can create curriculum based on the skills companies need their employees to master.”
N.C. State’s Centennial Campus offers research opportunities and partnerships that benefit students and businesses. More than 70 government and nonprofit entities have a presence on the campus and all include students and faculty in their research and development. Over the past few years, more than 1,000 of those students have been hired as interns


N.C. Central University, one of the three Historically Black Colleges and Universities, is in the Triangle region.
or full-time employees. “There’s high demand for the talent that’s out there,” says Mike Schmidt, N.C. State’s associate vice chancellor for partnerships. “Companies are finding they need to be a lot more strategic in their relationships with universities to gain access to that talent. Most of the companies that are here on campus have a leg up. They are getting daily access to students and building almost a three-year job interview with the talent they want to recruit.”
Centennial Campus enhances the success rate of the startups it assists. Large companies that grew from small startups there include Red Hat and Phononic, which develops solid-state heating and cooling technology in Durham. The National Security Agency and U.S. Department of Agriculture are among the government tenants working with N.C. State to develop technology and solutions. The successful concept is being used as the model for East Carolina University’s millennial campus in Greenville.
A steady pipeline of highly skilled entry-level employees complements an existing critical mass of talent already working in the Triangle’s technology sector. “From a worker standpoint, you do not want to work for the only company in your industry,” Haley says. If a job doesn’t work out or you’re ready to go to the next level, then you need choices. “You want to know there are 15 other companies within a few miles that attract the same skill set and knowledge base,” he says.
The Triangle’s quality of life attracts residents and retains graduates. The evolution of downtown Raleigh over the past couple of decades has produced the type of urban living that’s popular with tech companies and their employees. “They all
head of The Crown Companies and a developer of the 170,000-square-foot workplace for software creator Citrix that opened in a former downtown warehouse in 2014.
Though Raleigh has always bustled with state-government workers, lawyers, bankers and business people, it shut down at 5 p.m. on most days. That changed when small businesses, residential developers and startups began dipping their toes into the city’s urban core at the turn of the century. Soon large employers, many in the tech space, became interested. Since 2015, more than 8,479 new residential units have gone up in downtown along with 2,102 hotel rooms, according to the Downtown Raleigh Alliance. Add to that, 3.5 million square feet of new office space and 732,000 square feet of new retail. Sidewalks are now full of people, café tables and dog bowls.
Wake County, at the heart of the Triangle, has more than a million residents, and more arrive every day. A WalletHub Study in August 2021 ranked the Durham and Cary real-estate markets as the seventh and 12th, respectively, hottest in the country. “There’s a reason why this community is one of the fastest growing metro regions in the United States,” Haley says. “There’s a lot of job opportunity, obviously, and there’s a really high quality of life. We are a community that invests in ourselves. We invest in open space. We invest in our schools. We invest in parks and greenways. Those are the quality-of-life components that provide that ‘stickiness factor.’ People come here and want to stay.”
Wake County voters approved a half-cent sales tax to finance public transportation improvements in 2016. Those included a Bus Rapid Transit system with 20 miles of dedicated


efficient transit to locations throughout the county. The 5-mile New Bern Avenue line, for example, is slated to open in 2024. Federal funds will cover about $35 million of its $76 million cost.
Raleigh is investing in more ways. It paid $52 million for a former state hospital just south of downtown in 2015. It became Dix Park, whose 308 acres makes it one of the country’s largest public greenspaces. Shady groves of trees, ball fields, meadows and an all-faiths chapel attract hundreds of visitors each week. A field of sunflowers is popular in social media posts. Guided walking tours, yoga in the park and artist talks take place regularly. Long-term plans continue to evolve but include a children’s museum, nature trails and a waterfall.
There’s a long history of public and private funding of the arts in the Triangle. It’s home to the North Carolina Symphony, Carolina Ballet and North Carolina Museum of Art as well as many smaller museums and arts performance groups.
Sporting events are popular, too. College basketball rivalry Tobacco Road runs right through the region. It’s home to the NHL’s Carolina Hurricanes, who won the Stanley Cup in 2006. And the North Carolina Courage, a professional women’s soccer team based in Cary, was league champion in 2018 and 2019. The team’s majority owner is informationtechnology entrepreneur Steve Malik, while tennis great Naomi Osaka is an investor.

The North Carolina Museum of Natural Sciences, one of the state’s most-visited museums, is home to the 72-foot tall Daily Planet, a hollow steel globe covered in high-resolution satellite photos of the Earth.

RISING HIGHER
Western North Carolina’s beautiful views, recreational opportunities and unique amenities create a quality of life that’s hard to match anywhere else. The COVID-19 pandemic highlighted those benefits, attracting more people and businesses to the mountains. While new development often brings good things, it also creates challenges. Following in the footsteps of the region’s hardy Scotch-Irish settlers, community and business leaders are digging in, working hard and creating clever responses. Seven experts from the region gathered to discuss the issues, solutions and how they can be leveraged for an even better future.
BRITTANY BRADY
president and CEO, Henderson County Partnership for Economic Development
GREG BURNETTE
area executive, Raleigh-based First Citizens Bank
KIT CRAMER
president and CEO, Asheville Area Chamber of Commerce
TOM DEMPSEY
founder and CEO, Brevard-based SylvanSport
JOHN GOSSETT
president, Asheville-Buncombe Technical Community College
DEBORAH MURRAY
executive director, Caldwell County Economic Development Commission
BEN TEAGUE

vice president of strategic development, Asheville-based Biltmore Farms







WESTERN SNAPSHOT COUNTIES:
Alleghany
Ashe Avery
Buncombe
Burke
Caldwell

Cherokee Clay Graham Haywood Henderson Jackson Macon
Madison
McDowell
Mitchell
Polk
Rutherford Swain
Transylvania
Watauga
Wilkes
Yancey
BIGGEST COLLEGES AND UNIVERSITIES
Western Carolina University, Cullowhee
UNC Asheville
Appalachian State University, Boone
Asheville-Buncombe Technical Community College
ATTRACTIONS
Biltmore Estate, Asheville
Blue Ridge Parkway
Nantahala Outdoor Center, Bryson City
Tryon International Equestrian Center, Mill Spring
Sliding Rock, Transylvania County
North Carolina Arboretum, Asheville
Grandfather Mountain, Linville
Chimney Rock State Park, Chimney Rock
Linville Caverns, Marion
Cherokee Cultural Attractions, Cherokee
Tweetsie Railroad, Blowing Rock
INDUSTRIES
Aerospace and defense
Furniture
Craft beer
Data centers
Tourism
Advanced manufacturing
Christmas trees
WHAT CHALLENGES DID COVID PRESENT? WHAT DID IT TEACH YOU?
MURRAY: The past year was tough, but it was amazingly good, too. Furniture manufacturing was hit fast and hard. Our unemployment rate jumped to 16.3% in April 2020. It hadn’t been that high since the Great Recession. We’ve recovered for the most part — unemployment was 4.5% in April 2021, according to the most recent data from N.C. Department of Commerce. But the labor shortage and supply chain issues are causing fits as they are elsewhere. Caldwell County had one of its best years for new private investment and number of completed projects. Our project pipeline remains full and busy. Partnerships and collaborations were the best things to come from the past year. The highest levels of leadership in health care, education, government, business and industry — everybody had a seat at the table. We meet regularly and will continue to as we move forward.
BURNETTE: While the region fared well over the past year, there were businesses, especially in the hospitality industry, that suffered. Many of them displayed resiliency, flexibility and adaptability, whether it was a restaurant moving to carryout only while on the fly or a manufacturer shifting to personal protective equipment production. Hospitality businesses continue to deal with the pandemic’s effects as they bounce back. Manufacturers are doing well.
BRADY: When the world shut down in March 2020, we thought, we thought we would have two weeks to work on pet projects. Boy, we were wrong. The first two weeks were dedicated to figuring out what was happening. Our manufacturing community was deemed essential, so its members needed to find ways to safely continue their work. We saw the pandemic’s problems and its opportunities. We had a company locate here instead of expanding internationally. We saw health care continue to thrive with Jabil’s $38 million expansion into Henderson County. It’s expected to create 150 jobs by 2025 The county’s unemployment rose to 14.6% in April 2020, falling to 3.6% one year later. But unemployment in the advanced manufacturing sector was still 10% in late May 2021. When it comes to the jobs that our organization caters to, we believe that the workforce is about 15,000 people short. We’re trying to be resilient and creative, keeping the momentum, meeting supply and demand, and fostering a successful manufacturing community.
TEAGUE: The past year was an interesting time. Biltmore Farms has hotels, office space and retail. Its land holdings include the 1,000-acre planned development Biltmore Park West, where aviation manufacturer Pratt & Whitney is investing $650 million to build a 1-million-square-foot factory and create 800 jobs. It’s expected to start manufacturing turbine airfoils next year. When the tide of good fortune ebbs, you discover who you are and what you’re made of. The region’s brand is strong. People come here to live healthy lives. They view it as a respite, an outdoor mecca kind of place. But the pandemic also uncovered some of the region’s softer points. Hospitality can’t support everybody. It can’t be the mainstay
of how we thrive. There were times over the past year, for example, when only a handful of Biltmore Farms’ hundreds of hotel rooms were booked. So, we have to continue to focus on manufacturing, corporate roles and creating career ladders, not just jobs. That’s what this Pratt & Whitney project represents. Many of its jobs pay about $70,000 annually. That’s a huge chunk of capital being injected into the market. But they also bring intellectual capital for our community. We’re excited about that. The region has a bright future.
CRAMER: It has been the best of times and worst of times. We went from being No. 1 in the state with low unemployment to being at the top of that list soon after the pandemic’s start. Our great restaurants, unique small businesses and hotels were quickly and severely impacted by shutdowns and stay at home orders. We’ve rebounded by about 24,000 jobs, but our working population remains below prepandemic levels. There’s a tendency for people statewide to see us as tourism dependent. But we’re more than tourism. We landed Pratt & Whitney, the region’s largest manufacturing project in terms of investment and new jobs. The basics of our economy are strong, and I’m bullish about the future.
DEMPSEY: We were at full stop in late March 2020. A truckload of exhibit materials was pulling away from our loading dock when we told its driver not to leave. We shifted to PPE production within a week. That kept our team working. It was fortuitous that we could shift quickly. If we waited one more week, it would have been too late. We are a manufacturer and a tourist destination. Almost a thousand families pick up their camper at our factory each year, and many immediately start their vacation in western North Carolina. Our complete shift to selling direct to consumers began at the end of 2019, and our timing couldn’t have been better. The outdoor industry exploded about midway through 2020 as people pursued one of the only activities that respected pandemic-induced directives. We’ve set business records each month since July 2020. It’s a little awkward succeeding while others struggle because of no fault of their own. But we look at the silver lining and count our blessings.
GOSSETT: A-B Tech never closed because of the pandemic. We were still teaching. Students attended lectures online and only visited campus for labs and clinicals. I’m proud of my team, who implemented COVID precautions, keeping the pandemic at bay on campus. But people were still fearful. And like most community colleges nationwide and all but a few in North Carolina, our enrollment declined. Broadband internet access contributed to that as did access to internet-capable devices. When K-12 schools switched to remote learning, many moms and dads stayed home. We discovered that if those families had only one device, the school-aged child had first dibs. Mom and dad were forced to use it late at night or early in the morning. That pressure was too much, so many stepped away from their studies or workforce development opportunities. We understand that people were forced to make choices. We hear that they want to return to campus. We’re expecting an enrollment jump this fall.

housing supply. We want them to focus on workforce housing. We need as much workforce housing as possible included in developments. We’ve been discussing ways to encourage it with local governments.
GOSSETT: We’ve had some prospective employees turn down a job offer because of living costs. If we stay within our pay scale, they can’t afford housing. It’s disheartening. So, we have been developing local talent — people who already are living and playing in Buncombe County.
BURNETTE: Real estate in the region has become very attractive. More people are moving here from densely populated places, attracted by the quality of life. There’s been a digital shift — individuals realizing that technology allows them to work from anywhere — underway for many years. But the pandemic is pushing that transformation. We need homebuilders to recognize this need. If I have property, how can I maximize the return on investment versus positively impact the community. The public and private sectors have to continue to talk about it and take action. There are a variety of programs to finance homes, so it’s not a capital issue. It’s an inventory issue.
MURRAY: The economic developer’s role has changed. A few years ago, it was novel to say you’re more about the holistic aspects of economic development. That’s the only way it works today. Our housing issue is tough. The Great Recession stopped housing development. We have aging single family and multifamily homes. Our first new multifamily housing project that’s not subsidized housing happened in 2021. We’re celebrating, believing it will lead to more similar projects. We have the same approach to single family development. We need low-, middle- and high-tier housing. Many local employers mention losing potential employees because of not
because we need to fill the growing labor gap.
BRADY: It seems every time I pick up the newspaper, another proposed development has gone before city council or the planning department. The housing challenge comes with opportunities. We’ve developed a relocation guide, which we wouldn’t have done five years ago. It will help us land talent, including giving locals who left for college and hadn’t considered returning home a reason to move back. And so just like there is short term, midterm and longterm strategies for workforce development, we believe there is short term, midterm and long-term strategies for housing.
DEMPSEY: About half of our employees are from Henderson County. Some are from Buncombe County, and some are from upstate South Carolina. We’re recruiting for many technical positions, which pay well, but we’ve had to increase pay to cover living costs. I personally have helped find housing for folks that we want to hire. We just brought in a talented engineer from Texas. Fortunately, he and his wife live in a tiny house, so they relocated it to a tiny house village in Henderson County. If everyone could have that circumstance, it would lift a huge burden. We also are developing internal talent as it has becomes more difficult to relocate people quickly.
TEAGUE: It doesn’t matter how much you pay a person: It’s a problem if there’s nowhere for their child to go for a safe and quality education, especially as we leave the pandemic behind and more people return to work. And it’s not enough to just create jobs. Getting on the bottom rung of the career ladder is good. And having high-end jobs is good. But it’s not good if you have to leave the region to climb the rungs in between. We must create opportunities, so people can work their way up that ladder.
Hendersonville
WHAT ARE SOME OF THE REGION’S NEEDS? HOW CAN THEY BE ADDRESSED?
GOSSETT: I came here in the middle of the pandemic. People made an effort to reach out to me, including A-B Tech in what they are doing and allowing us to share what we’re doing. That collaborative attitude is exciting. We can’t live in silos. We have to work together; the lift is much lighter when we do. At a recent strategic planning meeting, we discussed more than which programs to add or subtract. We want to change higher education’s culture. In the past, students were on their own, and only the strong survived. We can’t do that anymore. We have to reach out to students and remove barriers, including offering childcare and helping them land jobs. Those weren’t discussed when I started in higher education 30 years ago. They’re discussed daily today.
TEAGUE: Western North Carolina needs its regional perspective. We collaborate until the time that we need to compete. I serve on the local advisory board of HCA Healthcare Mission Fund, a $25 million effort that invests in local companies working in the health care industry, helping them scale up through the nation’s largest health care system based on the number of hospital beds. That’s extremely powerful for venture ready companies. The Pratt & Whitney project includes five community colleges, led by A-B Tech. It’s important to pool our resources so people can bring everything to the table. We’re a great location for divisional or small corporate headquarters — operations of 50 to 250 employees. We would celebrate those opportunities, which historically have gone to big cities. If you draw a 60-mile radius around Biltmore Park, for example, there are 2 million people. If you think of Greenville and Asheville as one, it’s similar in size to Charlotte or Raleigh. Companies that value a high quality of life in high quality places have never been more mobile. So, what attracts people to the region is a real economic opportunity moving forward.
DEMPSEY: I was part of the team that created Economic Development Partnership of North Carolina’s Office of Outdoor Industry. Several outdoor gear manufacturers have located in western North Carolina over the past year. It’s evidence that North Carolina is the East Coast’s leader in the Outdoor Recreation Industry. Our state’s outdoor assets are recruitment tools that appeal to companies in all industries. SylvanSport is a founding member of North Carolina Outdoor Recreation Coalition, which functions as a support mechanism at the state level. It’s bringing national and international attention to those amenities and the quality of life they create. Western North Carolina recently launched the Made by Mountains brand — MadeXMtns — which highlights the reasons why outdoor industry companies and brands are here.
WHAT DOES THE FUTURE HOLD FOR YOU AND THE REGION?
DEMPSEY: We’re excited about the future, including how electric vehicles will shape the recreational vehicle industry. SylvanSport is positioned to lead that change. Our current product line is well suited for that purpose, and we have some dynamic development and engineering going on in towables expressly designed for EVs. We have a lot of fun stuff on the horizon.
BRADY: The Partnership worked with Henderson County and Hendersonville to develop 41-acre Garrison Industrial Park — where Jabil is building — at the end of last year. And to Joe Q. Public, that’s not a big deal. But we’ve literally moved mountains for economic development in western North Carolina. Its topography is a challenge for site development. The park is a historic joint venture, and we’re excited to expand the career pipeline in our community.
CRAMER: In addition to the pandemic, the country underwent a racial justice awakening over the past year. Through our work, including community visioning, we identified economic mobility of residents as one of our focuses. We received a Golden LEAF grant to help fund inclusive hiring partners. Chamber staff is working with companies that want to hire residents who are held back by generational poverty, a past interaction with the justice system or a history of substance abuse. I’m excited about the business community’s enthusiasm for the project, which is being undertaken in partnership with the housing authority, A-B Tech and several community-based nonprofits. We’re confident it will move people up the economic ladder for the long term.
BURNETTE: As we reached mid-2020, when there was still a lot of uncertainty about the pandemic and its effects, we were in the middle of a conversion of a bank in western North Carolina. That added difficulty to everything else that was happening. Looking forward, we’re working on a merger with [New York-based] CIT Group, which will make First Citizens one the country’s top 20 banks. It will positively impact the region and open doors, including giving us access to verticals, such as rail and other specialized lending.
MURRAY: We’ve been growing a life sciences and biotech cluster over the last eight years, adding several hundred jobs annually. We anticipate that its growth will accelerate within the next two years. It’s providing great opportunities and increasing the local average wage. We’re developing a world-class pharmacy tech program through the community college that will benefit pharmaceutical manufacturers here and across the region. That’s a turning point for us. We recently put under contract the land for the county’s first new industrial park in more than 20 years. It’s adjacent to the aforementioned cluster. It’s part of the diversification of our local economy that has been underway since the Great Recession.


READY TO HELP
Businesses expand or locate in North Carolina for many reasons, including financial incentives and grants. Here are some of what’s available and the investments they helped make possible.
DISCRETIONARY GRANTS
Job Development Investment Grants provide performance-based incentives directly to new and expanding businesses. They help offset the cost of establishing or expanding in the state.
The One North Carolina Fund awards cash grants based on the number of jobs created, investment made, location selected and economic impact projected.
In 2018, legislators approved a Transformative Project provision of the JDIG grant program. To qualify, companies must create at least 3,000 jobs and invest at least $1 billion within 10 years.
Building Demolition and Building Reuse grants provide funds for site rehabilitation and renovation of vacant industrial and commercial buildings.
TIERED TAX CREDITS
North Carolina annually assesses the economic health of its 100 counties. Each is assigned to one of three tiers. Projects in the 40 most distressed counties — Tier 1 — for example, are eligible for greater tax credits than those in the 20 least distressed, Tier 3.
source: North Carolina Department of Commerce

FEELING GREAT
The COVID-19 pandemic brought an economic malaise to most of the world. But many businesses, especially those in technology, manufacturing and financial services, made healthy investments and added jobs in North Carolina. Here are some of the largest announcements from the past year.

APPLE
CUPERTINO, CALIF.
NEW JOBS: 3,000
COUNTIES: WAKE AND CATAWBA
PROJECTED INVESTMENT: $1 BILLION
N.C. INCENTIVES: $846 MILLION OVER 39 YEARS
Apple will invest $550 million in a Wake County campus plus about $450 million to expand its Catawba County data center, which opened in 2009. The Wake site near Cary and Morrisville is expected to eventually employ 3,000 in research, operations and engineering. The jobs will have an average annual salary of about $187,000, according to the company. Apple already employs 1,100 in the state, including 200 at the Catawba center.

MOUNTAIN VIEW, CALIF. NEW JOBS: 1,000 COUNTY: DURHAM
PROJECTED INVESTMENT: N/A
N.C. INCENTIVES: N/A
As part of a $7 billion nationwide expansion in 2021, Google officials announced a 1,000-job cloudengineering hub in Durham, including as many as 500 by the end of 2023. It will be one of five Google Cloud engineering centers nationwide as the searchengine giant competes with Amazon and Microsoft in cloud computing. Google didn’t seek incentives for the project. The search-engine giant has operated a data center in Caldwell County since 2007.

PRATT & WHITNEY
EAST HARTFORD, CONN.
NEW JOBS: 800
COUNTY: BUNCOMBE
PROJECTED INVESTMENT: $650 MILLION
N.C. INCENTIVES: $15.5 MILLION OVER 12 YEARS
The pandemic wreaked havoc on commercial aviation and aerospace manufacturing, prompting massive federal responses to prop up the industry. But Pratt & Whitney’s plans for a $650 million aircraft-engine factory in Asheville proved the state’s economic resilience. The 1.3 million-square-foot complex, which is expected to open in 2022, is being built near Interstate 26 and the Blue Ridge Parkway on land owned by the Cecil family’s Biltmore Farms. It’s the biggest project in Buncombe County history.

FIDELITY INVESTMENTS
BOSTON
NEW JOBS: 750
COUNTY: DURHAM
PROJECTED INVESTMENT: N/A
N.C. INCENTIVES: N/A
Privately held Fidelity’s 2006 arrival at Research Triangle Park helped launch Raleigh and Durham as contenders for big financial-services campuses. The company has continued to grow to a local staff of more than 3,000 with two new waves of hiring announced in 2021. It’s hiring 750 mobile app development, customer service and financial advisory positions in North Carolina, mainly at the Durham site. Activity on the company’s mobile and web-based platforms spiked by about 60% during the pandemic, helping Fidelity add 8.6 million customer accounts since the beginning of 2020.

FUJIFILM
DIOSYNTH BIOTECHNOLOGIES
TOKYO
NEW JOBS: 750
COUNTY: WAKE
PROJECTED INVESTMENT: $2 BILLION
N.C. INCENTIVES: $21.7 MILLION OVER 12 YEARS
Formed by Dutch and Japanese owners, the biotech company announced the state’s first $2 billion plant in March 2020. It chose Wake County, where it employs 600 in Morrisville, over College Station, Texas. With support from the N.C. Biotechnology Center and others, the company will produce cell cultures in the fast-growing community of Holly Springs, which also is home to a 500,000-square-foot biomanufacturing plant that Swiss multinational Novartis opened in 2009. It’s now called Seqirus.

CREDIT KARMA
SAN FRANCISCO
NEW JOBS: 600
COUNTY: MECKLENBURG
PROJECTED INVESTMENT: $13 MILLION
N.C. INCENTIVES: $20.3 MILLION OVER 12 YEARS
Credit Karma announced it was expanding its Charlotte operation in May 2021. The move will take five years, and the annual salary for the new jobs is expected to average $157,000. Intuit, which owns TurboTax and QuickBooks, bought the consumerfinance and marketing company for $8.1 billion in 2020. Credit Karma has operated an office in Ballantyne since 2017. It plans to create a high-tech engineering center that will employ analysts, software engineers and managers.

NORTH CAROLINA’S LARGEST PRIVATE COMPANIES
For more than 30 years, Business North Carolina magazine has recognized privately owned businesses that play pivotal, but often understated, roles in building the state’s economy. Its list, compiled with revenue and employment information shared by companies, includes best estimates for those that prefer not to disclose that information. Private equity controlled companies whose operations are based in North Carolina are eligible for the list. The majority of businesses are closely held organizations with long histories in the state. The list is based on 2020 revenue, reflecting a year heavily affected by the COVID-19 pandemic.

retailer
Art Pope
7,000 (estimate)
Poultry, pork producer
CEO: William H. “Bill” Prestage
Convenience-store supplier
CEO: Sherwin Herring Employees: 236
Dealer of construction & other equipment
CEO: Ed Weisiger Jr.
1,450
installation service CEO: Tammy Whitworth
750 (estimate)
Goldsboro
Turkey producer
CEO: H.G. Maxwell III Employees: 650 (estimate)
Charlotte
General contractor
CEO: Patricia A. Rodgers Employees: 328
Wilmington
Distributor of industrial packaging materials and paper converter
CEO: Russell M. “Rusty” Carter Employees: 1,305
Raleigh
Dealer of construction & other equipment
CEO: J. Gregory Poole III Employees: 1,272 27.
Hickory
Manufacturer of adhesive tape, consumer goods and office supplies
CEO: Vuk Trivanovic Employees: 1,500
Raleigh
General contractor
CEO: Tim Clancy Employees: 400
Jefferson
General contractor
CEO: Eddie Vannoy
Employees: 341
Rocky Mount
General contractor
CEO: Robert Barnhill III
Employees: 890
19. Prestage Farms
Southco Distributing
CTE
23. Goldsboro Milling
24. Rodgers Builders
25. Atlantic Packaging
26. Gregory Poole Equipment
Shurtape Technologies
28. Clancy & Theys Construction
29. Vannoy Construction
30. Barnhill Contracting
NORTH CAROLINA’S LARGEST PUBLIC COMPANIES
Business North Carolina magazine used stock-market performance as of June 30, 2021 to determine this list of the 50 largest public companies headquartered in North Carolina. Fueled by a market rebound that followed the COVID-19 pandemic panic of early 2020, some tripled in value. The star performer was Belmont-based Piedmont Lithium — No. 49 — which shot up more than 11-fold, aided by a big contract to supply electric automaker Tesla. Old Dominion Freight Line, SPX, PRA Health and Cree repeated as four of the best stock market performers over the past five years. PRA was acquired in July by Ireland-based Icon, while PPD and Select Bancorp have also announced plans to be sold.
1. Bank of America

2. Honeywell
Diversified holding company
5. Truist Financial
6. Iqvia Holdings
7. Trane Technologies
8. Old Dominion Freight Line
9. Nucor
10. Laboratory Corporation of America Holdings
11. Qorvo Greensboro Semiconductors
12. Martin Marietta Materials Raleigh Building materials
13. Ingersoll Rand Davidson Industrial goods
14. Albemarle Corp. Charlotte Chemicals
15. PPD Wilmington Health care services
16. Dentsply Sirona Charlotte Medical supplies
17. Advance Auto Parts Raleigh Specialty retail
18. Cree Durham Semiconductors and LED lighting
19. PRA Health Sciences Raleigh Pharmaceutical services
20. Syneos Health Raleigh Pharmaceutical services
21. Sealed Air
Charlotte Containers and packaging
22. First Citizens BancShares
Raleigh Financial services
23. Hanesbrands Winston-Salem Apparel
24. Hayward Holdings Charlotte Electronic components
25. nCino Wilmington Computer software
26. Vontier Raleigh Industrial machiner
27. Driven Brands Charlotte Automotive services
28. Curtiss-Wright Charlotte Aerospace and industrial equipment
29. Highwoods Properties
Raleigh Real estate
30. CommScope Hickory Telecommunications equipment
31. Premier
Charlotte Health care services
32. Brighthouse Financial Charlotte Financial services
33. Coca-Cola Bottling Co. Consolidated Charlotte Soft drinks
34. Bandwidth Raleigh Software
35. Kontoor Brands Greensboro Apparel
36. Phreesia Raleigh Managed health care
37. Krispy Kreme
Charlotte Specialty retail
38. Lending Tree
Charlotte Financial services
39. BioCryst Pharmaceuticals
Durham Pharmaceutical
40. SPX
Charlotte Industrial equipment
41. SPX FLOW
Charlotte Industrial equipment
42. Jeld-Wen
Charlotte Building products
43. Live Oak Bancshares
Wilmington Financial services
44. Cornerstone Building Brands
Cary Industrial goods
45. Avaya Raleigh Retail computer software and peripheral equipment
46. EnPro Industries
Charlotte Industrial equipment
47. Tanger Factory Outlet Centers Greensboro Shopping centers
48. Sonic Automotive
Charlotte Car dealerships
49. Piedmont Lithium Belmont Precious metals
50. First Bancorp Troy Financial services



NORTH CAROLINA HIGHER EDUCATION DIRECTORY
PUBLIC UNIVERSITIES
APPALACHIAN STATE UNIVERSITY Boone | appstate.edu
CAROLINAS COLLEGE OF HEALTH SCIENCES Charlotte | carolinascollege.edu
EAST CAROLINA UNIVERSITY Greenville | ecu.edu
ELIZABETH CITY STATE UNIVERSITY Elizabeth City | ecsu.edu
FAYETTEVILLE STATE UNIVERSITY Fayetteville | uncfsu.edu
NORTH CAROLINA AGRICULTURAL AND TECHNICAL STATE UNIVERSITY Greensboro | ncat.edu
NORTH CAROLINA CENTRAL UNIVERSITY Durham | nccu.edu
NORTH CAROLINA STATE UNIVERSITY Raleigh | ncsu.edu
UNC ASHEVILLE Asheville | unca.edu
UNC CHAPEL HILL Chapel Hill | unc.edu
UNC CHARLOTTE Charlotte | uncc.edu
UNC GREENSBORO Greensboro | uncg.edu
UNC PEMBROKE Pembroke | uncp.edu
UNC SCHOOL OF THE ARTS Winston-Salem | uncsa.edu
UNC WILMINGTON Wilmington | uncw.edu
WESTERN CAROLINA UNIVERSITY Cullowhee | wcu.edu
WINSTON-SALEM STATE UNIVERSITY Winston-Salem | wssu.edu
PRIVATE INSTITUTIONS
BARTON COLLEGE Wilson | barton.edu
BELMONT ABBEY COLLEGE Belmont belmontabbeycollege.edu
BENNETT COLLEGE Greensboro | bennett.edu
BREVARD COLLEGE Brevard | brevard.edu
CABARRUS COLLEGE OF HEALTH SCIENCES Concord | cabarruscollege.edu
CAMPBELL UNIVERSITY Buies Creek | campbell.edu
CAROLINA CHRISTIAN COLLEGE Winston-Salem | carolina.edu
CAROLINA COLLEGE OF BIBLICAL STUDIES Fayetteville | ccbs.edu
CAROLINA UNIVERSITY Winston-Salem | piedmontu.edu
CATAWBA COLLEGE Salisbury | catawba.edu
CHAMBERLAIN UNIVERSITY NORTH CAROLINA Charlotte | chamberlain.edu
CHARLOTTE CHRISTIAN COLLEGE AND THEOLOGICAL SEMINARY Charlotte | charlottechristian.edu
CHOWAN UNIVERSITY Murfreesboro | chowan.edu
DAVIDSON COLLEGE Davidson | davidson.edu
DEVRY UNIVERSITY Charlotte, Raleigh | devry.edu
DUKE UNIVERSITY Durham | duke.edu
ECPI UNIVERSITY Charlotte, Greensboro, Raleigh ecpi.edu
ELON UNIVERSITY Elon | elon.edu
GARDNER-WEBB UNIVERSITY Boiling Springs | gardner-webb.edu
GRACE COLLEGE OF DIVINITY Fayetteville | gcd.edu
GREENSBORO COLLEGE Greensboro | greensboro.edu
GUILFORD COLLEGE Greensboro | guilford.edu
HERITAGE BIBLE COLLEGE Dunn | heritagebiblecollege.edu
HIGH POINT UNIVERSITY High Point | highpoint.edu
JOHNSON & WALES UNIVERSITY Charlotte | jwu.edu/charlotte
JOHNSON C. SMITH UNIVERSITY Charlotte | jcsu.edu
LEES-MCRAE COLLEGE Banner Elk | lmc.edu
LENOIR-RHYNE UNIVERSITY Asheville, Hickory | lr.edu
LIVING ARTS COLLEGE Raleigh | living-arts-college.edu
LIVINGSTONE COLLEGE Salisbury | livingstone.edu
LOUISBURG COLLEGE Louisburg | louisburg.edu
MARS HILL UNIVERSITY Mars Hill | mhu.edu
MEREDITH COLLEGE Raleigh | meredith.edu
METHODIST UNIVERSITY Fayetteville | methodist.edu
MID-ATLANTIC CHRISTIAN UNIVERSITY Elizabeth City | macuniversity.edu
MILLER-MOTTE COLLEGE Fayetteville, Jacksonville, Raleigh, Wilmington | miller-motte.edu
MONTREAT COLLEGE Montreat, Black Mountain montreat.edu
NORTH CAROLINA WESLEYAN COLLEGE Rocky Mount | ncwc.edu
NORTHEASTERN UNIVERSITY Charlotte, online northeastern.edu/charlotte
PFEIFFER UNIVERSITY Misenheimer, Charlotte, Raleigh-Durham | pfeiffer.edu
QUEENS UNIVERSITY OF CHARLOTTE Charlotte | queens.edu
ST. AUGUSTINE’S UNIVERSITY Raleigh | st-aug.edu
SALEM COLLEGE Winston-Salem | salem.edu
SHAW UNIVERSITY Raleigh | shawu.edu
SOUTHEASTERN BAPTIST THEOLOGICAL SEMINARY Wake Forest | sebts.edu
SOUTHEASTERN FREE WILL BAPTIST BIBLE COLLEGE Wendell | sfwbc.edu
ST. ANDREWS UNIVERSITY Laurinburg | sa.edu
STRAYER UNIVERSITY Charlotte, Concord, Greensboro, Huntersville, Morrisville, Raleigh strayeruniversity.edu
UNIVERSITY OF MOUNT OLIVE Mount Olive, Durham, Goldsboro, Jacksonville, New Bern, Smithfield, Washington, Wilmington umo.edu
UNIVERSITY OF PHOENIX Charlotte | phoenix.edu
WAKE FOREST UNIVERSITY Winston-Salem | wfu.edu
WARREN WILSON COLLEGE Swannanoa | warren-wilson.edu
WATTS SCHOOL OF NURSING Durham | wattsschoolofnursing.org
WESTERN GOVERNORS UNIVERSITY Durham, online | wgu.edu
WILLIAM PEACE UNIVERSITY Raleigh | peace.edu
WINGATE UNIVERSITY
Wingate, Charlotte, Hendersonville wingate.edu

COMMUNITY COLLEGES
ALAMANCE COMMUNITY COLLEGE Burlington, Graham alamancecc.edu
ASHEVILLE-BUNCOMBE
TECHNICAL COMMUNITY COLLEGE Arden, Asheville, Candler, Marshall, Woodfin | abtech.edu
BEAUFORT COUNTY COMMUNITY COLLEGE Washington | beaufortccc.edu
BLADEN COMMUNITY COLLEGE Dublin | bladencc.edu
BLUE RIDGE
COMMUNITY COLLEGE
Brevard, Flat Rock, Hendersonville blueridge.edu
BRUNSWICK
COMMUNITY COLLEGE
Bolivia, Carolina Shores, Leland, Southport | brunswickcc.edu
CALDWELL COMMUNITY COLLEGE AND TECHNICAL INSTITUTE Boone, Hudson | cccti.edu
CAPE FEAR COMMUNITY COLLEGE
Burgaw, Castle Hayne, Hampstead, Wilmington | cfcc.edu
CARTERET COMMUNITY COLLEGE Morehead City | carteret.edu
CATAWBA VALLEY COMMUNITY COLLEGE Conover, Hickory, Newton, Taylorsville | cvcc.edu
CENTRAL CAROLINA COMMUNITY COLLEGE
Dunn, Lillington, Pittsboro, Sanford, Siler City | cccc.edu
CENTRAL PIEDMONT COMMUNITY COLLEGE
Charlotte, Huntersville, Matthews cpcc.edu
CLEVELAND
COMMUNITY COLLEGE Shelby | clevelandcc.edu
COASTAL CAROLINA
COMMUNITY COLLEGE Jacksonville | coastalcarolina.edu
COLLEGE OF THE ALBEMARLE
Barco, Edenton, Elizabeth City, Manteo | albemarle.edu
CRAVEN COMMUNITY COLLEGE Havelock, New Bern | cravencc.edu
DAVIDSON COUNTY
COMMUNITY COLLEGE
Bermuda Run, Lexington, Mocksville, Thomasville davidsonccc.edu
DURHAM TECHNICAL
COMMUNITY COLLEGE Durham, Hillsborough durhamtech.edu
EDGECOMBE COMMUNITY COLLEGE
Rocky Mount, Tarboro edgecombe.edu
FAYETTEVILLE TECHNICAL COMMUNITY COLLEGE
Fayetteville, Fort Bragg, Spring Lake | faytechcc.edu
FORSYTH TECHNICAL COMMUNITY COLLEGE Kernersville, King, Walnut Cove, Winston-Salem | forsythtech.edu
GASTON COLLEGE Belmont, Dallas, Lincolnton gaston.edu
GUILFORD TECHNICAL COMMUNITY COLLEGE Colfax, Greensboro, High Point, Jamestown | gtcc.edu
HALIFAX COMMUNITY COLLEGE Weldon | halifaxcc.edu
HAYWOOD COMMUNITY COLLEGE Clyde | haywood.edu
ISOTHERMAL COMMUNITY COLLEGE Columbus, Rutherfordton, Spindale | isothermal.edu
JAMES SPRUNT COMMUNITY COLLEGE Kenansville | jamessprunt.edu
JOHNSTON COMMUNITY COLLEGE Clayton, Four Oaks, Smithfield johnstoncc.edu
LENOIR COMMUNITY COLLEGE Kinston, La Grange, Pink Hill, Snow Hill, Trenton | lenoircc.edu
MARTIN COMMUNITY COLLEGE Williamston, Windsor martincc.edu
MAYLAND COMMUNITY COLLEGE Burnsville, Newland, Spruce Pine mayland.edu
MCDOWELL TECHNICAL COMMUNITY COLLEGE Marion | mcdowelltech.edu
MITCHELL COMMUNITY COLLEGE Mooresville, Statesville mitchellcc.edu
MONTGOMERY COMMUNITY COLLEGE Troy | montgomery.edu
NASH COMMUNITY COLLEGE Rocky Mount | nashcc.edu
PAMLICO COMMUNITY COLLEGE Bayboro, Grantsboro pamlicocc.edu
PIEDMONT COMMUNITY COLLEGE Roxboro, Yanceyville piedmontcc.edu
PITT COMMUNITY COLLEGE Winterville | pittcc.edu
RANDOLPH COMMUNITY COLLEGE Asheboro | randolph.edu
RICHMOND COMMUNITY COLLEGE Hamlet, Laurinburg richmondcc.edu
ROANOKE-CHOWAN COMMUNITY COLLEGE Ahoskie | roanokechowan.edu
ROBESON COMMUNITY COLLEGE Lumberton | robeson.edu
ROCKINGHAM COMMUNITY COLLEGE Wentworth | rockinghamcc.edu
ROWAN-CABARRUS COMMUNITY COLLEGE Concord, Kannapolis, Salisbury rccc.edu
SAMPSON COMMUNITY COLLEGE Clinton | sampsoncc.edu
SANDHILLS COMMUNITY COLLEGE Pinehurst (main), Raeford, Robbins, Carthage | sandhills.edu
SOUTHEASTERN COMMUNITY COLLEGE Whiteville | sccnc.edu
SOUTH PIEDMONT COMMUNITY COLLEGE Monroe, Polkton, Wadesboro spcc.edu
SOUTHWESTERN COMMUNITY COLLEGE Sylva | southwesterncc.edu
STANLY COMMUNITY COLLEGE Albemarle, Locust | stanly.edu
SURRY COMMUNITY COLLEGE Dobson, Elkin, Mount Airy, Pilot Mountain, Yadkinville | surry.edu
TRI-COUNTY COMMUNITY COLLEGE Marble, Murphy, Robbinsville tricountycc.edu
VANCE-GRANVILLE COMMUNITY COLLEGE Creedmoor, Henderson, Louisburg, Warrenton | vgcc.edu
WAKE TECHNICAL COMMUNITY COLLEGE Cary, Morrisville, Raleigh, Wake Forest, Zebulon | waketech.edu
WAYNE COMMUNITY COLLEGE Goldsboro | waynecc.edu
WESTERN PIEDMONT COMMUNITY COLLEGE Morganton | wpcc.edu
WILKES COMMUNITY COLLEGE Sparta, West Jefferson, Wilkesboro wilkescc.edu
WILSON COMMUNITY COLLEGE Wilson | wilsoncc.edu
Business north Carolina’s list of the state’s best hospitals with 50 or more beds examines data compiled from several sources to determine which medical centers provide the best care for their patients.
The rankings are calculated using more than 25 metrics, including information provided by the U.S. Centers for Medicare & Medicaid Services. Patient-satisfaction surveys, as well as infection, readmission and death rates for common procedures, are also taken under consideration.
Other factors include safety report cards by the Washington, D.C.-based nonprofit The LeapfrogGroup, distinction awards from insurer Blue Cross and Blue Shield, and national performance ratings from U.S. News & World Report
UNC REX HEALTHCARE
RALEIGH
Beds: 660
President: Ernie Bovio
President/COO: Chad Setliff 1 2 3 4
DUKE UNIVERSITY HOSPITAL
DURHAM Beds: 957
President: Thomas Owens
CAROMONT REGIONAL MEDICAL CENTER
GASTONIA
Beds: 435
President/CEO: Chris Peek
FIRSTHEALTH MOORE REGIONAL HOSPITAL
PINEHURST
Beds: 390
CEO: Mickey Foster
MISSION HOSPITAL
ASHEVILLE
Beds: 730
CEO: Chad Patrick
ATRIUM HEALTH CABARRUS
CONCORD
Beds: 457
Facility Executive: Asha Rodriguez
CAROLINAEAST
MEDICAL CENTER
NEW BERN
Beds: 350
President/CEO: Raymond Leggett III
MOSES CONE HOSPITAL
GREENSBORO
Beds: 529
President: Preston Hammock
NOVANT HEALTH FORSYTH MEDICAL CENTER
WINSTON-SALEM
Beds: 921
UNC HOSPITALS
CHAPEL HILL
Beds: 929
CEO: Donald Gintzig 10 11 12 13 TIE
President: Janet Hadar
NOVANT HEALTH
PRESBYTERIAN MEDICAL CENTER
CHARLOTTE
Beds: 597
President/COO: Saad Ehtisham
ATRIUM HEALTH CAROLINAS
MEDICAL CENTER
CHARLOTTE
Beds: 907
President, central division: Vicki Block
DUKE REGIONAL HOSPITAL
DURHAM
Beds: 369
President: Katie Galbraith
WAKE FOREST BAPTIST
HEALTH - HIGH POINT REGIONAL MEDICAL CENTER
HIGH POINT
Beds: 351
CEO: James Hoekstra
WAKE FOREST BAPTIST
MEDICAL CENTER
WINSTON-SALEM
Beds: 885
CEO: Julie Ann Freischlag
ATRIUM HEALTH PINEVILLE
CHARLOTTE
Beds: 235
President/CEO: Michael Lutes
FRYE REGIONAL
MEDICAL CENTER, A DUKE LIFEPOINT HOSPITAL
DURHAM
Beds: 369
President: Katie Galbraith
WAKEMED RALEIGH
CAMPUS
RALEIGH
Beds: 726
NOVANT HEALTH MATTHEWS MEDICAL CENTER
MATTHEWS
Beds: 146
President/COO: Jason Bernd
ALAMANCE REGIONAL MEDICAL CENTER
BURLINGTON
Beds: 238
President: Mark Gordon
ATRIUM HEALTH UNION MONROE
Beds: 249
President/CEO: Michael Lutes
NEW HANOVER REGIONAL MEDICAL CENTER
WILMINGTON
Beds: 769
President: John Gizdic
CAPE FEAR VALLEY
MEDICAL CENTER
FAYETTEVILLE
Beds: 666
CEO: Michael Nagowski
CATAWBA VALLEY
MEDICAL CENTER
HICKORY
Beds: 156
SVP/admin: Edward Beard
WAKEMED CARY HOSPITAL CARY
Beds: 156
Senior VP/admin: Thomas Gough
TOP PERFORMER
North Carolina is a great place to do business. But you don’t have to take our word for it. The state’s competitive tax rates, infrastructure, customized workforce development and quality of life are a few of the reasons it consistently ranks as a top state for businesses. #1
Site Selection magazine, 2021 #1
Forbes, 2017, 2018 and 2019 #1
Development Counsellors International, 2020
LARGEST CITIES
CNBC, 2021
Tax Foundation, 2021 #3 #2 TOP STATES FOR BUSINESS
Business Facilities magazine, 2021
ALAMANCE
Alamance Chamber of Commerce
336-228-1338 alamancechamber.com

LARGEST PRIVATE-SECTOR EMPLOYER Laboratory Corporation of America
LARGEST
ALEXANDER
alexanderedc.org

HIGHER
ALLEGHANY
Alleghany County Chamber of Commerce

ASHE
EMPLOYMENT
336-372-5473 alleghanycountychamber.com EMPLOYMENT
Ashe County Economic Development
336-846-5501
ashencedc.com

BEAUFORT
Beaufort County Economic Development
252-946-3970
beaufortedc.com

LARGEST
LARGEST
ANSON
Anson Economic
Development Partnership 704-690-4936 ansonedp.com

AVERY
Avery County Economic Development Committee 828-504-2045 averycounty.com/edc
LARGEST PRIVATE-SECTOR EMPLOYER American Emergency Vehicles
LARGEST

BERTIE
Bertie County Economic Development 252-794-5301 co.bertie.nc.us

Roanoke-Chowan Community College; Martin Community College
BLADEN
Bladen County Economic Development Commission 910-645-2292 bladennc.govoffice3.com

EMPLOYMENT BY INDUSTRY Manufacturing: 46.1% Government: 6.9%
LARGEST PRIVATE-SECTOR EMPLOYER Smithfield Foods
LARGEST CITY/TOWN Elizabethtown: population 3,275
COUNTY PROPERTY TAX 82.0 cents per $100 value
HIGHER EDUCATION Bladen Community College
BUNCOMBE
Economic Development Coalition Asheville-Buncombe County 828-258-6101
ashevillechamber.org/economic-development

EMPLOYMENT BY INDUSTRY
LARGEST PRIVATE-SECTOR EMPLOYER Mission Health
LARGEST CITY/TOWN Asheville: population 94,855
COUNTY PROPERTY TAX 48.8 cents per $100 value
HIGHER EDUCATION
UNC Asheville; Montreat College; Warren Wilson College; Asheville-Buncombe Technical Community College
CABARRUS
Cabarrus Economic Development

CAMDEN
EMPLOYMENT BY INDUSTRY
16.0%
12.9%
704-704-703-1725 cabarrusedc.com EMPLOYMENT BY INDUSTRY
Camden County Economic Development Commission 252-338-6363, ext. 312 camdencountync.gov

LARGEST PRIVATE-SECTOR EMPLOYER Amazon.com
LARGEST CITY/TOWN Concord: population 105,936
COUNTY PROPERTY TAX
74.0 cents per $100 value
HIGHER EDUCATION Barber-Scotia College; Rowan-Cabarrus Community College; Cabarrus College of Health Sciences
BRUNSWICK
Brunswick Business and Industry Development 910-408-1603
brunswickbid.com

BURKE
Burke Development Inc. 828-764-9370 burkedevinc.com

CALDWELL
Economic Development Commission of Caldwell County 828-728-0768 caldwelledc.org

CARTERET
Carteret County Economic Development Department 252-648-7880 carteretedc.com
LARGEST PRIVATE-SECTOR EMPLOYER Boddie Noell Enterprises
LARGEST CITY/TOWN

CASWELL

CHATHAM
Caswell County Office of Economic Development 336-933-4674 allincaswellnc.com EMPLOYMENT
LARGEST PRIVATE-SECTOR EMPLOYER WS Construction
LARGEST
CATAWBA
Catawba County Economic Development Corp. 828-267-1564 catawbaedc.org

HIGHER
LARGEST

CHOWAN
Chatham County Economic Development Corp. 919-542-8274 chathamedc.org EMPLOYMENT BY INDUSTRY
Edenton Chowan Partnership Inc. 252-482-2007 edenton.net

LARGEST PRIVATE-SECTOR EMPLOYER Vidant Health
LARGEST CITY/TOWN Edenton: population 4,454
CHEROKEE
Cherokee County Economic Development 828-835-9564, ext. 204 cherokeecounty-nc.gov

CLAY
Clay County Economic Development 828-389-0089 economic.claync.us

HIGHER EDUCATION College of The Albemarle
CLEVELAND
Cleveland County Economic Development Partnership
704-669-4701 chooseclevelandcountync.com

COLUMBUS
Columbus County Economic Development Commission 910-640-6608 columbusedc.com

HIGHER EDUCATION Southeastern Community College
CRAVEN
Craven County Economic Development
252-633-5300 cravenbusiness.com

EMPLOYMENT BY INDUSTRY Government: 17.8% Health care: 17.6%
LARGEST PRIVATE-SECTOR EMPLOYER CarolinaEast Health System
LARGEST CITY/TOWN New Bern: population 31,240
COUNTY PROPERTY TAX
cents per $100 value
HIGHER EDUCATION
Craven Community College
CURRITUCK
Currituck County Economic Development
252-232-6015 thinkcurrituck.com

LARGEST PRIVATE-SECTOR EMPLOYER Food Lion
LARGEST CITY/TOWN Myock, unincorporated COUNTY
DAVIDSON
Davidson County Economic Development Commission 336-243-1900 davidsoncountyedc.com

EMPLOYMENT BY INDUSTRY Manufacturing:
LARGEST PRIVATE-SECTOR EMPLOYER Atrium
CUMBERLAND
Fayetteville Cumberland County Economic Development Corp 910-500-6464 fayedc.com

DARE
The Outer Banks Chamber of Commerce 252-441-8144 outerbankschamber.com

DAVIE
Davie County Economic Development Commission 336-751-2714 daviecountyedc.com

HIGHER EDUCATION
DUPLIN
Duplin County Economic Development Commission 910-296-2180 duplinedc.com

DURHAM
Greater Durham Chamber of Commerce 919-328-8750 durhamchamber.org

EDGECOMBE

FRANKLIN
FORSYTH
Carolinas Gateway Partnership 252-442-0114 econdev.org EMPLOYMENT BY INDUSTRY
Franklin County Economic Development Commission 919-554-1863 franklincountync.us

GATES

GRANVILLE
EMPLOYMENT BY INDUSTRY
LARGEST PRIVATE-SECTOR EMPLOYER QVC
LARGEST CITY/TOWN Rocky Mount (part): population 15,359
COUNTY
HIGHER EDUCATION Edgecombe Community College
Greater Winston-Salem Inc. 336-728-9200 winstonsalem.com

GASTON
Gaston County Economic Development Commission 704-825-4046 gaston.org
LARGEST PRIVATE-SECTOR EMPLOYER Novozymes North America
LARGEST
cents per $100
HIGHER EDUCATION Louisburg College; Vance-Granville Community College
Gates County Chamber of Commerce 252-506-1592 gatescountync.gov EMPLOYMENT
Granville County Economic Development Commission 919-693-5911 granvillecounty.org

EMPLOYMENT BY INDUSTRY
LARGEST PRIVATE-SECTOR EMPLOYER Ultracare Management Group
LARGEST CITY/TOWN Gatesville: population 265
COUNTY PROPERTY TAX
cents per $100 value
HIGHER EDUCATION College of The Albemarle

GRAHAM
Graham County Economic Development 828-479-7984 grahamcountyedc.org

GREENE
Greene County Economic Development Commission 252-747-3446 greenecountync.gov

HIGHER EDUCATION Lenoir Community College
GUILFORD
Greensboro Chamber of Commerce
336-387-8310, greensboro.org
High Point Economic Development Corp. 336-883-3116, highpointnc.gov

EMPLOYMENT BY INDUSTRY Health care: 13.3% Manufacturing: 11.1%
LARGEST PRIVATE-SECTOR EMPLOYER Cone Health
LARGEST CITY/TOWN Greensboro: population 299,556
COUNTY PROPERTY TAX
73.1 cents per $100 value
HIGHER EDUCATION
Bennett, Guilford and Greensboro colleges; High Point and NC A&T State universities; UNC Greensboro; Guilford Technical Community College
HARNETT
Harnett County Economic Development Commission 910-893-7524 harnettedc.org

HENDERSON
Henderson County Partnership for Economic Development
828-692-6373 gohendersoncountync.org

cents per $100 value
HIGHER EDUCATION Campbell University; Central Carolina Community College
HALIFAX
Halifax County Economic Development Commission 252-519-2630
halifaxdevelopment.com

HAYWOOD
Haywood Economic Development Council 828-456-3021 haywoodchamber.com

HERTFORD
EMPLOYMENT BY INDUSTRY Health care: 17.7% Retail: 14.4%
LARGEST PRIVATE-SECTOR EMPLOYER Pardee Hospital LARGEST CITY/TOWN Hendersonville: population 16,115
HIGHER EDUCATION Blue Ridge Community College
HOKE
Raeford Hoke Economic Development Commission 910-875-6113 hokecounty.net

Hertford County Economic Development 252-358-7801 hertfordcountync.gov

HYDE
Hyde County Office of Planning and Economic Development 252-926-4178 hydecountync.gov

IREDELL
Iredell Economic Development Corp.
704-663-1898
iredelledc.com

LARGEST PRIVATE-SECTOR EMPLOYER
Lowe’s
LARGEST
JACKSON
Jackson County Office of Economic Development, 828-631-2240 jacksonthrive.jacksonnc.org Jackson County Chamber of Commerce 800-962-1911, mountainlovers.com

Mitchell
JOHNSTON
Johnston County Economic Development 919-205-1232
growwithjoco.com

LEE
Sanford Area Growth Alliance
919-774-8439
growsanfordnc.com/edc

LINCOLN
Lincoln Economic Development Association
704-732-1511 lincolneda.org

LARGEST
JONES
Jones County Economic Development 252-448-1315 jonescountync.gov

LENOIR
Lenoir County Economic Development 252-527-1963 lenoiredc.com
LARGEST

MACON
Macon County Economic Development Commission 828-369-2306 maconedc.com

MADISON
Madison County Economic Development Board
828-649-1377
investinmadison.com

EMPLOYMENT BY INDUSTRY
LARGEST PRIVATE-SECTOR EMPLOYER Mars Hill University
LARGEST CITY/TOWN Mars Hill: population 2,006
COUNTY PROPERTY TAX 50.0 cents per $100 value
HIGHER EDUCATION Mars Hill College; Asheville-Buncombe Technical Community College
MCDOWELL
McDowell Economic Development Association Inc.
828-652-9391
mcdowellnceda.govoffice3.com

LARGEST PRIVATE-SECTOR EMPLOYER Baxter International
LARGEST
MARTIN
Martin County Economic Development Corp. 252-789-4904 martincountyedc.com

MECKLENBURG
Charlotte Regional Business Alliance 704-378-1300 charlotteregion.com

MITCHELL

MOORE
Mitchell County Economic Development Commission 828-537-1404 mitchellcountyedc.org EMPLOYMENT
Moore County Partners in Progress 910-246-0311 moorebusiness.org

LARGEST PRIVATE-SECTOR EMPLOYER Sibelco North America
LARGEST CITY/TOWN Spruce Pine: population 2,194
MONTGOMERY
Montgomery County Economic Development 910-576-4221, ext. 1308 montgomerycountync.com

NASH
Carolina Gateway Partnership 252-442-0114, econdev.org
Nash County Economic Development 252-462-2027, selectnashnc.com

NEW HANOVER
Wilmington Business Development 910-763-8414
wilmingtonbusinessdevelopment.com

EMPLOYMENT
LARGEST PRIVATE-SECTOR EMPLOYER New Hanover Regional Medical Center
LARGEST
COUNTY
HIGHER
ONSLOW
Jacksonville Onslow Economic Development 910-939-7023 joednc.com

PAMLICO
Pamlico County Office of Economic Development
252-745-3081
pamlicocounty.org

PENDER
Wilmington Business Development
910-763-8414 wilmingtonbusinessdevelopment.com

EMPLOYMENT
LARGEST
LARGEST
NORTHAMPTON
Northampton County Economic Development Commission 252-534-1092. ext. 4301 northamptonnc.com

ORANGE
Orange County Economic Development 919-245-2325 orangecountync.gov

PASQUOTANK
Elizabeth City Pasquotank County Economic Development Commission 252-338-0169 elizabethcitypasquotankedc.com

PERQUIMANS
Perquimans County Economic Development Commission 252-312-5314 econdevperquimansnc.com

PERSON
Person County Economic Development Commission
336-597-1752
personcountyedc.com

LARGEST PRIVATE-SECTOR EMPLOYER GKN Automotive Components
LARGEST CITY/TOWN Roxboro: population 8,131
PITT
Pitt County Economic Development Commission 252-902-2075 locateincarolina.com

HIGHER
POLK
Polk County Office of Economic Development
828-894-2895 polkedc.com

LARGEST PRIVATE-SECTOR EMPLOYER Acts
LARGEST
RANDOLPH
Randolph County Economic Development Corp. 336-626-2233 rcedc.com

RICHMOND
Richmond County Economic Development 910-997-8190 richmondnced.com

ROCKINGHAM
Rockingham County Center for Economic Development, Small Business & Tourism 336-342-8138 gorockinghamcountync.com

EMPLOYMENT
ROBESON
Robeson County Office of Economic Development 910-739-7584 robesoncountyoed.org
LARGEST CITY/TOWN Rockingham: population 9,199 COUNTY PROPERTY TAX
HIGHER

ROWAN
Rowan EDC Partnership for Economic Development 704-637-5526 rowanedc.com

RUTHERFORD
Rutherford County Economic Development
828-287-6200 rutherfordncedc.com

LARGEST PRIVATE-SECTOR EMPLOYER Rutherford Regional Health System
LARGEST
COUNTY
HIGHER
SCOTLAND
Scotland County Economic Development Corp.
910-266-4326
scotlandcountyedc.org

STOKES
Stokes County Economic Development 336-593-2497

SWAIN
LARGEST
LARGEST
SAMPSON
Sampson County Economic Development Commission 910-592-8921 sampsonedc.com

STANLY
Stanly County Economic Development Commission 704-986-3682 stanlyedc.com

SURRY
EMPLOYMENT BY INDUSTRY
stokesedc.com EMPLOYMENT
Swain County Economic Development Commission
828-488-7838 swaincountync.gov

LARGEST PRIVATE-SECTOR EMPLOYER Defender Services
LARGEST
(part):
HIGHER
Surry County Economic Development Partnership 336-401-9900 surryedp.com

TRANSYLVANIA
Transylvania Economic Alliance 828-393-4130 transylvaniaalliance.com

TYRRELL
Tyrrell County Economic Development
tyrrellcounty.org

EMPLOYMENT BY INDUSTRY
LARGEST PRIVATE-SECTOR EMPLOYER
Capt. Charlie’s Seafood
LARGEST CITY/TOWN Columbia: population 590
UNION
Monroe-Union County Economic Development 704-282-5780 developunion.com

HIGHER
Beaufort County Community College
VANCE
Henderson-Vance County Economic Development Commission
252-492-2094
vancecountyedc.com

WARREN
Warren County Economic Development Commission 252-257-3115
warrencountync.org

LARGEST PRIVATE-SECTOR EMPLOYER Variety Wholesalers
LARGEST
WAKE
Wake County Economic Development 919-664-7000 raleigh-wake.org

WASHINGTON
EMPLOYMENT
LARGEST PRIVATE-SECTOR EMPLOYER Glen Raven
LARGEST CITY/TOWN Norline: population 917
HIGHER
WATAUGA
Watauga County Office of Economic Development
828-264-3082 wataugaedc.org

Washington County Economic Development 252-793-5823 washconc.org

WAYNE
Wayne County Development Alliance 919-731-7700 waynealliance.org

WILKES
Wilkes Economic Development Corp.
336-838-1501
wilkesedc.com

YADKIN
Yadkin County Economic Development Council 336-679-2200
yadkinedc.com

WILSON
Wilson Economic Development Council 252-237-1115 wilsonedc.com

YANCEY
Yancey County Economic Development Commission 828-682-7722 yanceyedc.org

SOURCES
Population, counties, largest city/town, employment and unemployment rate: N.C. Office of State Budget and Management. Hyde and Currituck counties have no incorporated towns. Employment share by industry sector and largest private-sector employer: N.C. Department of Commerce Labor and Economic Analysis Division, as of fourth quarter of 2020. 2021-22 property-tax rate: N.C. Department of Revenue. Per capita income: U.S. Bureau of Economic Analysis. Community colleges are listed for every county in their designated service area.
*Per capita income is for 2019, the most recent year available.
REGIONAL ECONOMIC DEVELOPMENT PARTNERSHIPS
CHARLOTTE REGIONAL BUSINESS ALLIANCE
JANET LABAR, PRESIDENT AND CEO jlabar@charlotteregion.com 330 S. Tryon Street Charlotte, NC 28202 charlotteregion.com | 704-378-1300
Serves Alexander, Cabarrus, Catawba, Cleveland, Gaston, Iredell, Lincoln, Mecklenburg, Rowan, Stanly and Union counties in North Carolina and four South Carolina counties.
ECONOMIC DEVELOPMENT
PARTNERSHIP
OF NORTH CAROLINA
CHRISTOPHER CHUNG, CEO clientservices@edpnc.com 150 Fayetteville Street, Suite 1200 Raleigh, NC 27601 edpnc.com | 919-447-7777
Serves the state, working with regional and local partners to help businesses relocate and grow.
MOUNTAIN WEST PARTNERSHIP
125 Bonnie Lane Sylva, NC 28779 gownc.org | 828-586-1962
Serves Cherokee, Clay, Graham, Haywood, Jackson, Macon and Swain counties and Eastern Band of Cherokee Indians.

NCEAST ALLIANCE
VANN ROGERSON, PRESIDENT AND CEO rogerson@nceast.org 209 E. Fifth Street Greenville, NC 27858 nceast.org | 252-482-4333
Serves Beaufort, Bertie, Camden, Carteret, Chowan, Craven, Currituck, Dare, Duplin, Edgecombe, Gates, Greene, Halifax, Hertford, Hyde, Jones, Lenoir, Martin, Northampton, Onslow, Pamlico, Pasquotank, Perquimans, Pitt, Tyrrell, Washington, Wayne and Wilson counties.
NORTH CAROLINA’S SOUTHEAST
STEVE YOST, PRESIDENT locate@ncse.org
707 W. Broad Street, P.O. Box 2556 Elizabethtown, NC 28337 ncse.org | 910-862-8511
Serves Serves Anson, Bladen, Brunswick, Columbus, Craven, Cumberland, Duplin, Hoke, Lenoir, Montgomery, Moore, New Hanover, Onslow, Pender, Robeson, Sampson, Scotland and Wayne counties.
PIEDMONT TRIAD PARTNERSHIP
STAN KELLY, CEO; MIKE FOX, PRESIDENT* info@ptpnc.com 416 Gallimore Dairy Road, Suite M Greensboro, NC 27409 piedmonttriadnc.com | 336-668-4556
Serves Alamance, Caswell, Davidson, Davie, Forsyth, Guilford, Montgomery, Randolph, Rockingham, Stokes, Surry and Yadkin counties.
RESEARCH TRIANGLE REGIONAL PARTNERSHIP
RYAN COMBS, EXECUTIVE DIRECTOR rcombs@researchtriangle.org P.O. Box 110351
Research Triangle Park, NC 27709 researchtriangle.org | 919-670-2819
Serves Chatham, Durham, Franklin, Granville, Harnett, Johnston, Lee, Nash, Person, Wake, Warren and Wilson counties and Research Triangle Park.
*Fox will add CEO duties in May 2022.
ECONOMIC DEVELOPMENT PARTNERSHIP OF NORTH CAROLINA
Christopher Chung, CEO 919-447-7788
christopher.chung@edpnc.com edpnc.com
EDPNC BUSINESS / INDUSTRY DEVELOPMENT AND RECRUITMENT CLIENT SERVICES
919-447-7744
clientservices@edpnc.com edpnc.com
EDPNC EXPORT ASSISTANCE
Mike Hubbard, director of international trade 919-447-7757
mike.hubbard@edpnc.com edpnc.com/start-or-grow-a-business/ export-assistance
EDPNC TOURISM
Wit Tuttell, vice president 919-447-7740 wit.tuttell@visitnc.com visitnc.com
N.C. DEPARTMENT OF COMMERCE
Susan Fleetwood, executive director of economic development 919-814-4605 sfleetwood@nccommerce.com nccommerce.com
N.C. BOARD OF SCIENCE, TECHNOLOGY & INNOVATION
John Hardin, executive director 919-814-4639
jhardin@nccommerce.com nccommerce.com/sti
NORTH CAROLINA ECONOMIC DEVELOPMENT ASSOCIATION
Lawrence Bivins, managing director 888-246-2332
lawrence@nceda.org nceda.org
STATE LIBRARY OF NORTH CAROLINA
Susan Forbes, assistant state librarian 919-814-6786
susan.forbes@ncdcr.gov statelibrary.ncdcr.gov
UNC SYSTEM
General administration
919-962-1000 northcarolina.edu
N.C. COMMUNITY COLLEGE SYSTEM
Bruce Mack, vice president of economic development 919-807-7150
mackb@nccommunitycolleges.edu nccommunitycolleges.edu
NORTH CAROLINA INDEPENDENT COLLEGES AND UNIVERSITIES
A. Hope Williams, president 919-832-5817
williams@ncicu.org ncicu.org
NORTH CAROLINA ASSOCIATION OF REALTORS
Andrea Bushnell, CEO 336-294-1415
abushnell@ncrealtors.org ncrealtors.org
NORTH CAROLINA LEAGUE OF MUNICIPALITIES
Paul Meyer, executive director 919-715-3930
pmeyer@nclm.org nclm.org
NORTH CAROLINA CHAMBER
Gary Salamido, president and CEO 919-836-1403
gsalamido@ncchamber.com ncchamber.com
N.C. STATE PORTS AUTHORITY
Brian Clark, executive director 910-763-1621
brian.clark@ncports.com ncports.com

Cowee Mountain Overlook on the southern end of the Blue Ridge Parkway

